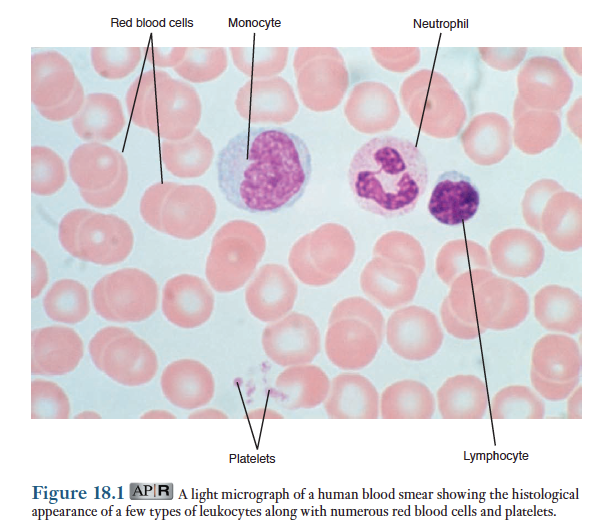

스스로 치유 능력의 핵심용어는 "면역학"이다.
아무리 능력이 우수한 군사를 가지고 있어도
그 군사가 제대로 활용되지 못하면 싸움에서 진다.
우수한 능력의 면역세포도 마찬가지인듯!!
cross-talk
면역세포의 능력을 통합하는 것은 무엇일까?
이러한 궁금증과 함께 인류의 선배 면역학 탐구자들에게 깊은 존경과 감사를 보냅니다
panic bird...
면역학(immunology)은 인체가 비자기성분(외래물질)으로부터 자기 성분을 인식하는 생리적 방어기전을 다루는 학문임. 이 과정에서 인체는 생물 혹은 무생물인 외래물질을 파괴하거나 중화시킴. 면역방어에서 자기성분을 비자기성분과 구별하는 과정에서 1) 바이러스류, 세균류, 곰팡이류 들과 같은 미생물의 감염으로부터 보호하고 2) 미생물이 아닌 외래물질을 분리 혹은 제거하며 3) 체내에서 일어나는 암세포를 파괴하는 면역감시(immune survelliance)기능을 함.
면역방어, 즉 면역은 선천성 면역과 후천성(적응)면역의 두종류로 나눌 수 있음. 이 두 반응은 서로 상호작용함. 선천성 면역은 외래물질이나 외래 세포에 대한 특별한 인식과정을 갖지 않고 방어함. 이러한 방어기전은 외래물질이나 세포의 특징을 무시함. 이러한 이유때문에 선천성 면역은 비특이적 면역이라고 알려져 있음. 후천성 면역반응(adaptive immune response)은 림프구에 의해 외래물질이나 침입한 세포의 특별한 인식과정을 거침. 이어서 이들 외래물질 혹은 세포에 맞는 독특한 면역공력이 수행됨. 이러한 이유로 후천성 면역반응을 특이적 면역반응이라고 함. 선천성 면역반응과 후천성 면역반응은 동시에 일어남. 예를들어 선천성 면역구성요소는 후천성 면역반응으로 하여금 외래물질이나 병원체를 제거하는 효과적 기능들을 수행할 수 있도록 항원-특이림프구를 활성화 시키는 정보들을 제공해줌.
면역반응을 담당하는 세포를 알아보기 전에 박테리아와 바이러스를 소개함.
박테리아(세균)는 단세포 생물로서 세포막 밖에 세포벽을 갖고 있으나 세포질 내에서 막성기관이 없음. 박테리아는 이들이 복제하는 부위의 조직을 손상시킬 수 있으며, 세균들이 방출하는 독소가 혈액으로 들어가 신체의 다른 부위에서 생리적 기능들을 방해함.
바이러스는 핵산이 단백질 외피에 의해 둘러싸인 형태임. 박테리아와는 달리 바이러스는 대사에 필요한 효소체계와 단백질 합성에 필수적인 리보솜이 결여되어 있음. 따라서 이들은 스스로 복제할 수 없기 때문에 다른 세포 안으로 들어가 그 세포의 생화학적 기구를 이용함. 바이러스의 핵산은 숙주세포로 하여금 바이러스 복제에 필요한 단백질을 합성하게 하며 이에 필요한 뉴클레오티드와 에너지 또한 숙주세포의 것을 이용함. 숙주세포내에서의 바이러스 습성과 복제에 대한 영향은 바이러스의 종류에 따라 다름. 일반적으로 감기 바이러스를 포함한 일부 바이러스들은 세포내로 침입한 후 재빨리 증식하고 세포를 죽이며 그 다음 다른 세포들로 이동함. 생식기에 포진을 일으키는 바이러스 등 빠른 증식을 하기 전에 감염된 세포에 잠복하여 숙주세포의 손상을 야기함. 어떤 바이러스들은 감염된 세포를 암세로로 전환시킴.
1. 면역방어를 중개하는 세포질들과 분비물질들
면역반응을 수행하는 세포들이 면역계를 구성함. 이들은 소화기계나 비뇨기계와 같이 뚜렷한 기관계를 형성하는 것이 아님. 대신 이들은 인체 전체에 퍼져있는 혈액과 림프액 그리고 각 조직에 존재하는 다양한 세포들의 집단임. 면역방어에 관여하는 세포의 수가 많고 또한 이들이 분비하는 화학전달자들이 더 많기 때문에 이들 세포들과 매개체들에 관한 간략한 용어해설을 표 18-2에 기술.
면역계 세포들
1) 백혈구(leukocyte)
면역계에서 가장 많이 차지하는 세포는 여러가지 형태를 가지는 백혈구임. 백혈구는 골수계 세포와 림프계 세포 두그룹으로 나뉨. 골수계 세포들에는 호중구(neutrophil), 호염기구(basophil), 호산구(eosinophil), 단핵구(monocyte)가 있으며, 림프계 세포들에는 두종류인 B림프구(B세포)와 T림프구(T세포)의 림프구와 자연살생(natural killer, NK)세포 등이 있음.
백혈구는 적혈구와 달리 이동을 위해 혈액을 이용하고 그들이 기능을 수행할 조직들로 들어가 순환계를 떠남.
2) 형질세포(plasma cell)
형질세포는 확연한 어떤 세포의 계통에서 유래된 것이 아니고 면역반응이 일어나는 동안 B세포에서 분화된 것임. 이름과는 달리 형질세포는 그들의 모체 림프구에서 분화된 조직에서 주로 발견됨. 혈질세포의 주 기능은 항체들을 합성하고 분비하는 것임.
3) 대식세포(macrophage)
대식세포는 사실상 모든 기관과 조직에서 발견되며, 구조는 이들이 위치한 장소에 따라 다소 차이가 있음. 이들은 단핵구로부터 분화되는 세포로서 단핵구가 혈관을 통과하여 조직에 들어간 후 거기에서 대식세포로 전환됨. 대식세포는 외래에서 유래된 입자들이나 미생물들을 식균작용(phagocytosis)하는 주된 기능과 맥락을 같이하여 전략적으로 표적들과 잘 만날 수 있는 곳에서 머뭄. 예를들면, 이들은 외부환경과 접촉하는 여러 상피들에서 많은 수가 발견됨. 일부 기관들에서는 혈액과 림프액이 통과하는 관 주위의 조직에 존재함.
4) 수지상세포(dendrite cell)
한편 대식세포는 아니지만 대식세포와 유사한 기능들을 가지는 세포들의 집단들이 존재하는데 이를 수지상세포(dendrite cell)이라고 함. 그 생활사의 특정단계에서 형질막으로부터 특수한 돌기물질이 뻗어나와 이름지어짐. 이들은 운동성이 크고 거의 모든 조직에 흩어져 존재하지만 특히 소화관과 같이 내외 환경 경계부에 많이 존재함. 활성화되면 수지상세포들은 식균한 병원체들을 공정하고 림프관들을 따라 2차 림프기관으로 이동한 후 T세포들을 활성화 시킴.
5) 비만세포(mast cell)
비만세포는 결합조직에서 발견되며 특히 인체의 상피표면 바로 아래에 존재함. 이들은 특정한 골수세포에서 유래하며 혈액내로 들어간 후 혈관을 통과하여 결합조직으로 들어간 후 분화와 세포분열을 수행함. 그러므로 성숙한 비만세포는 호염기구와 여러면에서유사한 특성을 갖지만 일반적으로 혈액내에 존재하지 않는 것이 차이점. 비만세포의 가장 큰 특징은 매우 많은 수의 세포질 소낭을 가지고 있는데 이 소낭에서 히스타민과 같은 국소적으로 작용하는 화학전달자들이 분비됨.
아래표 참고
림프구는 후천성 면역반응에서 외래물질을 인식하는 세포이며, 면역반응의 모든 면에서 필수적임. 호중구, 단핵구, 대식세포 그리고 수지상세포는 다양한 기능을 가지고 있지만 특히 중요한 점은 염증 중재자의 분비와 식세포의 기능을 하는 것임. 식세포는 식균작용을 하는 모든 세포를 지칭함.
사이토카인들(cytokines)
면역계의 세포들은 숙주세포의 분열을 조절하고 선천성 면역반응과 후천성 면역반응에서 기능을 담당하는 수없이 많은 단백질 전달자를 분비함. 이들 전달자들을 통틀어 사이토카인이라고 하며, 그 각각은 고유의 명칭을 가짐. 사이토카인들은 특정 분비선에서 생성되는 것이 아니라 각각의 다양한 세포에서 생성됨. 사이토카인들의 작용 대부분은 그들이 분비되는 부위에서 일어나므로 자가분비와 측분비라고 할 수 있음. 그러나 어떤 경우에는 사이토카인이 혈액으로 순환하여 숙주방어에 관련된 멀리 떨어진 기관과 조직에 대한 호르몬 효과를 수행하기도 함.
시토카인들은 면역계의 구성요소들을 서로 연결시킴. 이들은 화학적 정보교환의 네트워크로서 작용하며, 서로 다른 면역체계세포들 간의 대화를 가능케 함. 이러한 상호대화(cross-talk)는 면역체계 기능의 정확한 시기를 맞추는데 필수적임. 대부분의 시토카인들은 한 종류 이상의 면역세포에서 분비되며, 또한 면역세포가 아닌 세포에서도 분비됨.(예, 내피세포와 섬유아세포) 한 시토카인이 다른 시토카인을 분비하게 하고 그 시토카인이 또다른 시토카인을 분비하는 연속분비를 수행하기도 함. 어떤 시토카인은 표적세포의 범위가 매우 넓게 작용하기도 함. 예를들어 인터루킨-2는 모든 면역세포의 기능에 영향을 줌. 시토카인의 기능은 많이 중복되는데, 즉 서로다른 시토카인이 매우 비슷한 효과를 나타낼 수 있음. 시토카인은 또한 뼈의 형성이나 자궁의 기능 등과 같은 많은비면역 반응에도 관여함.
표참고. 이 장에서 몇몇 주요 시토카인들과 그들이 가장 중요한 기능들에 대해 논의함.
2. 선천성 면역반응(innate immune respones)
선천성 면역반응은 외래세포나 물질을 특정한 인식작용없이 방어함. 그러나 이러한 방어도 침투하는 외래물질을 나타내는 일부 일반적인 분자적 표식을 인식하여야 함. 가장 일반적인 표식은 미생물의 세포벽에 있는 특정한 탄수화물이나 지질에서 발견됨. 다양한 순환단백질들(특히 보체계 단백질)뿐만 아니라 특정 면역계 세포들의 형질막 수용체들이 선천성 면역반응의 특정한 시기에 이들 탄수화물 혹은 지질과 결합할 수 있음. 탄수화물과 지질로 외래 세포의 존재를 확인하는 이러한 선천성 면역반응은 외래세포를 그들이 생산한 특정한 단백질로 인식하는 획득 면역반응과 구별됨. 선천성 면역반응은 염증이라 불리는 체표면에서의 반응과 인터페론이라 불리는 항 바이러스성 단백질을 포함함.
체표면에서의 방어
면역반응은 아니지만 미생물 침입에 대한 1차 방어선은 외부 환경에 노출되어 있는 경계부인 체표면으로부터 피부가 이에 해당됨.그 밖의 특수한 체표면 방어는 코입구에 있는 털, 그리고 기침과 재채기 반사 등임. 여러가지 피부샘, 침샘, 눈물샘들은 모두 항미생물성 화학물질을 분비하여 면역에서 보다 강력한 역할을 함. 항 미생물성 화학물질들에는 항체들, 세균 세포벽을 파괴할 수 있는라이소자임과 같은 효소들, 그리고 세균들이 그 적절한 기능을 위해 요구되는 철의 획득을 차단하는 락토페린이라는 철-함유 단백질 등이 있음.
호흡관이나 상부 내장관의 상피세포에서 분비되는 점액물질 또한 항미생물성 화학물질들을 함유하는데, 그러나 더 중요한 점은 점액이 끈적끈적하다는 것임. 점액에 부착된 입자들이 혈액으로 들어가는 것을 막아줌. 이들은 인두의 섬모운동에 의해 모아져 삼켜지거나 상피세포에 존재하는 대식세포에 의해 식작용을 당하게 됨. 마지막으로 15장에서 배운대로 몇가지가 살아남아 대장에서 콜로니를 형성하기도 하지만 위에서의 산분비가 미생물들을 죽임.
염증(inflammation)
염증은 감염이나 상처에 대응하는 국소적인 신체 방어기구임. 염증의 기능은 외래 침입자를 파괴하거나 불활성화시키고 조직을 수선시킬 준비를 하는 것임. 이 과정에 관여하는 핵심 매개체는 식균작용의 기능을 하는 세포들임. 앞에서 언급했듯이 호중구, 대식세포, 그리고 수지상세포들이 가장 중요한 식세포들임.
이절에서는 미생물의 침입에 의해 유발되는 선천성 면역반응인 염증에 관하여 설명하고자 함. 추위, 열 그리고 외상과 같은 여러 손상들에 의해 대부분 동일한 반응이 일어남. 나중에 언급하겠지만 염증반응은 많은 적응 면역반응을 수반하여 더욱 증폭됨. 표 18-3은 박테리아에 오염된 칼에 베었을때 야기되는 감염에 대한 전형적인 선천성 면역반응에서 일어나는 일련의 현상을 제시함.
표 18-3. 박테리아 감염에 대한 비특이적 국소 염증반응
# 박테리아의 조직내 침투 : 손상된 조직에서 화학물질을 분비
# 감염부위에 혈관 확장으로 혈류량 증가
# 감염된 부위의 모세혈관과 소정맥으로부터 들어오는 단백질의 투과성이 크게 증가되어 단백질이 확산하여 들어오고 간질액이 안으로 유입
# 주화성 : 소정맥의 백혈구들이 감염된 부위 간질액 안으로 이동
# 조직내 박테리아가 식균작용 혹은 다른 기전에 의해 파괴
# 조직 회복
염증은 국소적 발적, 부종, 발열 그리고 통증의 특징을 보임.
수많은 화학매개물질들이 염증에서 일어나는 일련의 현상을 유도하고 조절함. 아래 표 참조
염증에서 혈관확장과 같은 현상은 여러 매개물질에 의해 유발됨. 더욱이 어떤 한 매개물질이 여러 현상을 유발시키기도 함. 매개물질은 그들의 기원에 따라 두종류로 나눔. 1) 혈장에 순환하는 단백질에 효소가 작용하여 감염부위에서 생성되는 펩티드들(예 키닌) 2) 감염된 부위(손상된 세포, 비만세포)에 이미 존재한 세포 혹은 염증반응 동안에 안으로 들어간(호중구)세포에서 세포외액으로 분비되는 물질들임.
박테리아의 감염이 피부조직 바로 밑에서 일어났다는 가정하에 표 18-3에 언급한 각 단계를 차례로 살펴보기로 함. 만일 침입한 박테리아가 혈액이나 림프로 들어갔다면 다른 조직이나 기관에서도 비슷한 염증반응이 일어날 것임.
혈관 확장과 단백질 투과성 증가
다양한 화학 매개자들이 감염되거너 손상된 부위의 미세혈관의 대부분을 확장시킴. 매개물질은 또한 국소 모세혈관과 소정맥의 내피세포를 수축시켜 내피세포 사이의 간격을 확장시킴으로써 단백질에 대한 투과성이 증가함. 이러한 혈관변화에 대한 현상으로 1)염증부위의 혈류량의 증가는 단백질과 백혈구의 수송을 증가시키고 2) 단백질의 투과성 증가는 염증에 관여하는 혈장단백질(내피세포 안에 갇혀 있던)이 간질액으로 들어오는 결과를 갖게 함.
그러나 12장에서 언급했듯이 혈관 확장과 단백질에 대한 투과성 증가는 혈장이 간질액으로 침투하는 것을 야기해 부종이 형성됨. 이는 염증부위가 부풀어 오르는 것을 의미하며 단순히 미세순환 변화의 결과를 의미하는 것이지 그 자체가 어떤 특정한 적응성을 의미하는 것은 아님.
주화성(chemotaxis)
염증이 시작되면 순환하고 있던 호중구가 모세혈관과 소정맥의 내피세포를 거쳐 혈액으로 빠져나와 염증부위로 이동함. 이러한 전과정을 주화성이라 함. 이 과정은 내피세포와 호중구에 있는 다양한 단백질과 탄수화물로 구성된 부착분자(adhesion)들이 관여함. 이는 내피세포를 포함하여 손상된 부위에 있는 세포들에 의해 분비되는 전달자들이 이를 조절함. 이들 전달자들을 총체적으로 주화성 물질이라고 함.
첫번째 단계에서 호중구는 그 어떤 부착물질에 의해 내피세포에 느슨하게 부착됨. 호중구가 혈관표면을 따라 구르는데, 이것을 변연화(margination)이라고 함. 본질적으로 이러한 초기 가역적 현상은 호중구가 손상된 부위에 방출한 주화성 물질에 노출되게 함. 이러한 주화성 물질은 호중구에 작용하여 그 막에 있는 또 다른 종류의 부착물질을 유도함. 이 물질은 내피세포에 있는 특정분자와견고하게 결합함. 그 결과 호중구는 혈류에 의해 씻겨 내려가지 않고 손상부위로 모이게 됨.
다음단계는 삼출(diapedesis)이라 하는데, 호중구의 가는 돌기가 두 내피세포 사이로 삽입되고 전체 호중구가 내피세포벽에 압착되어 간질액으로 들어감. 이 과정에서 수많은 호중구는 조직손상이 일어난 부위로 이동함. 병원체 자극을 받은 선천성 면역세포들이 주화성 물질을 방출하기 때문에 이 과정이 일어남. 그러므로 호중구는 감염부위에 있는 미생물쪽으로 이동하는 경향이 있음. 백혈구가 손상부위로 이동하는 것은 호중구 뿐만 아님. 단핵구가 그 뒤를 잇게 되는데, 일단 그 조직내로 들어오면 이들은 대식세포로 전환되는 형태적, 기능적 변화를 수행함.
주화성이 여러형태의 백혈구 이동에 선택성과 유연성을 제공하는 것은 여러단계의 주화성 과정에서 중요한 일임. 백혈구마다 부착물질들이 다른 것은 서로 다른 주화성물질에 의해 조절되기 때문임. 이러한 점에서 특히 중요한 것은 서로 다른 종류의 백혈구에 작용하는 주화성 물질의 기능을 가지는 시토카인들임. 예를들면, 한 종류의 시토카인은 호산구를 자극함. 따라서 백혈구의 어느 한종류가 염증반응 동안에 특정시간, 특정조직으로 들어갈 수 있도록 자극되는 것은 침입자나 시토카인의 종류에 의해서 결정됨. 주화성 물질로 작용하는 시토카인들을 케모카인(chemokine)이라고 함.
식균작용(phagocytosis)
일단 호중구나 다른 백혈구들이 손상된 부위에 도착하면 이들은 식균작용에 의해 침입한 미생물을 파괴하기 시작함. 식균작용의 첫번째 단계는 식세포의 표면과 미생물간의 접촉임.
이렇게 접촉하는 동안 식균작용을 촉진하는 가장 중요한 것 중의 하나는 식세포의 수용체와 미생물 세포벽에 있는 탄수화물 혹은 지질과의 상호작용임. 그러나 젤라틴 같은 캡슐에 의해 둘러싸인 박테리아와 접촉은 그 자체가 식균작용을 촉진하는데 항상 필요한 것은 아님. 이때는 체내에서 생성된 화학인자가 식세포를 미생물에 견고하게 결합할 수 있게 하여 식균작용을 촉진시킴. 이와같이 식균작용을 촉진하는 물질들을 옵소닌(opsonin)이라고 함.
식세포가 미생물를 섭식할때, 식세포 안에서 미생물이 포함된 작은 주머니가 형성되는데 이것을 파고좀(phagosome)이라하며, 이는한층의 원형질막이 식세포의 세포질로부터 미생물을 분리시킨 것임. 파고좀 막은 이후 여러 가수분해 효소로 채워져 있는 식세포의 리소좀과 결합함. 파고좀과 리소좀막이 융합하여 파고리소좀이라 불리는 작은 소포를 형성. 파고리소좀 안에서 미생물의 거대분자는 리소좀에 있는 효소들에 의해 분해됨. 이회에도 파고리소좀 막에 있는 효소들은 과산화수소뿐 아니라 일산화질소 그리고 그밖의 산소유도체들을 생성시킴. 이러한 물질들은 미생물의 거대분자들에 강력한 파괴력을 가짐.
식세포가 미생물을 죽일 수 있는 방법은 이러한 세포내 파괴만 있는 것이 아님. 식세포는 또한 항미생물 물질을 세포외액에 분비하여 식균작용없이도 미생물을 죽일 수 있음. 이들 물질들 중 일부(예 NO)는 세포외액에 분비되어 염증 중개자의 기능을 수행하기도함. 따라서 식세포가 염증 부위로 들어가 미생물과 만나 케모카인을 포함하는 염증 중개자들을 분비하여 더 많은 식세포를 끌어 모으는 양성되먹임 기전이 일어나게 됨.
보체(Complement)
보체라고 알려진 혈장 단백질군은 식균작용없이 미생물을 죽일 수 있음. 어떤 보체단백질은 항상 불활성화된 상태로 혈액내를 순환함. 감염이나 손상에 반응하여 한보체 단백질이 활성화되면 두번째의 보체단백질을 활성화시키고 이는 다시 세번째의 보체를 활성화시키는 일련의 반응이 계속 진행됨. 이러한 방법으로 혈액내에 존재하는 불활성 보체가 감염된 부위의 세포외액에서 여러단계의 보체활성이 일어나게 됨. 이러한 보체활성은 적어도 30개의 서로 다른 단백질이 관여하는 복잡한 반응이므로 여기서는 몇가지 보체단백질만의 기능을 알아보기로 함.
보체 활성화 경로에서 중심적 역할을 하는 단백질인 C3임. C3의 활성화는 일련의 과정을 일으키는데, 첫번째가 C3성분의 하나인 C3b 를 미생물 표면에 부착하는 것임. C3b는 옵소닌으로 작용하여 식세포를 미생물과 접촉시켜 파괴시키도록 함. 아래그림 참조
C3b는 또한 연쇄반응경로 중 증폭시켜주는 가수분해 효소의 한 역할을 담당하여, 궁극적으로 다단위 단백질인 막공격 복합체(membrane attack complex, MAC)를 형성함. 이 막공격복합체는 미생물 원형질막에 박혀 막에 통로가 생기게 하고 그 미생뭉릐 세포 안쪽 내용물이 유출되어 나오게 함. 또 물과 이온 그리고 작은 분자들이 그 미생물내로 들어가서 미생물의 세포내 환경을 깨뜨려 미생물을 죽게 함. 미생물을 직접 죽이는 수단이외에도 보체계는 염증반응에서도 다른 중요한 기능을 함. 아래 그림.
연쇄경로에서의 일부 활성화된 보체분자들은 직, 간접적으로(다른 염증중개자들 분비를 자극) 혈관확장, 모세혈관의 단백질 투과성 증가 그리고 주화성을 야기함. 나중에 설명하겠지만 림프구에 의해 분비되는 단백질의 일종인 항체는 일련의 보체활성화 과정 중의 제일 첫번째 보체단백질(c1)을 활성화 시키는데 필요함. 그러나 림프구는 현재 설명하고 있는 선천성 염증반응에는 관여하지않음.
그러면 보체활성 반응은 선천성 염증반응 동안에 어떻게 시작되는 것일까? 그 답은 대체적 보체경로(alternate complement pathway)에 있는데, 이 경로는 항체에 의존하지 않으며 C1을 경유하지 않음. 대체 경로는 미생물의 표면에 있는 탄수화물과 C1이 아닌 다른 불활성 보체 분자와의 상호작용의 결과에 의해서 시작됨. 이러한 상호작용은 앞에서 언급한 옵소닌의 일종인 활성화된 C3b를 형성하고, 이후 일련의 보체활성경로를 거치게 됨. 그러나 모든 미생물들이 대체 경로를 수행시킬 수 있는 표면을 가지고 있는 것은 아님.
선천성 면역반응에 관여하는 또 다른 옵소닌
C3b이외에도 몇몇 혈장 단백질들은 미생물의 세포벽에 있는 탄수화물이나 지질에 선천성으로 결합할 수 있고, 옵소닌화를 수행함.c반응 단백질(C-reactive protein)과 같은 몇몇 단백질들은 간에서 형성되며 혈장에 일정한 농도를 유지함. 그러나 이들의 생성 및 혈장내에서의 농도는 염증반응 동안에 현저히 증가함.
조직수선
염증의 마지막 단계는 조직수선임. 조직에 따라 세포의 증식은 이 기간에 일어날 수도 있고, 일어나지 않을 수도 있음. 예를들어 간세포는 증식을 하지만, 골격근 세포는 증식하지 않음. 염증이 일어난 부위의 섬유아세포들은 빠르게 분열하여 많은 양의 콜라겐을 분비하기 시작하는 반면, 혈관세포들은 분열하여 혈관형성과정에 참여함. 이러한 모든 일들은 화학매개물질 특히 국소적으로 생성되는 일련의 성장인자들에 의해 일어남. 최종적으로 치유과정이 서서히 진행됨에 따라 리모델링이 일어남. 최종 조직수선이 완벽하지 않을때에는 흉터를 남김.
인터페론들(interferone)
인터페론은 시토카인의 한 종류로서 1형과 2형 두가지가 존재함. 1형 인터페론은 숙주내에 존재하는 바이러스의 증식을 비특이적으로 억제하는 몇가지 단백질들을 포함함. 대부분의 세포들은 바이러스 감염에 반응하여 이들 인터페론을 생산하여 세포외액으로 분비함. 이어서 방출된 1형 인터페론들은 그 분비세포와 바이러스에 감염여부와 관계없이 다른 세포의 세포막에 있는 수용체들에 결합함. 아래 그림.
이러한 결합은 세포로 하여금 여러종류의 항바이러스 성 단백질의 합성을 촉진시킴. 만약 세포가 이미 감염되어 있거나 감염된다면 이들 인터페론들이 바이러스의 복제능을 방해함. 1형 인터페론들은 또한 암세포들을 죽이기도 하며, 감염동안에는 열이 발생함.
앞에서 설명한 1형 인터페론들의 작용은 특이적이 아님. 많은 종류의 바이러스가 인터페론의 합성을 유발하며 그 인터페론은 또 다시 많은 종류의 바이러스가 인터페론의 합성을 유발하며, 그 인터페론은 또다시 많은 종류의 바이러스들의 증식을 억제함. 그러나 최근 연구에서 1형 인터페론들이 또한 적응 면역반응의 일부분에 영향을 주는 것이 알려짐.
또 다른 종류의 2형 인터페론(감마-인터페론이라고도 함)은 면역계 세포들에 의해서 생성됨. 이 인터페론은 1형 인터페론들 일부의 작용을 강화시켜 대식세포들의 식균능을 촉진시키며, 염증과정에서 하나의 케모카인으로 작용함.
Toll-유사 수용체들(Toll-like receptor)
이 절 도입부에서 선천성 면역은 하나의 면역세포가 미생물의 공통적인 분자 양상의 일부를 인식하는 것에 의존함을 언급한 바 있음. 이러한 분자 양상을 병원체-연관분자양상들(pathogen-associated molucular patterns, PAMPs)이라고 함.
그렇다면 이들에 대한 인식은 어떻게 이루어지는 것일까?
Toll-like receptor
이 단백질들이 혈장과 대식세포 및 수지상세포의 엔도솜 막에서 발현됨. 이 단백질 기능들 중 하나가 미생물과 연관된 매우 보존성인 PAMPs와 결합하는 것임. PAMPs에 포함되는 것이 여러 세균들에 존재하는 지질다당류와 그 외의 지질들, 탄수화물들 그리고 여러 세균들의 편모에 존재하는 단백질 등임. 이들 리간드들 중 하나가 형질막에 결합되면 면역세포들에서 2차 전달자들이 형성되고 그에 의해 인터류킨-1, 2 및 TNF-알파와 같은 염증매개자들이 분비됨. 이어서 이들이 선천성 면역에 관여하는 세포들의 활성화시킴.
많은 수의 Toll단백질들은 형질막-결합성을 가지며 세포외 리간드들과 결합하여 2차 전달자 형성을 유도하므로 그들을 수용체로 간주함. 따라서 이 계열의 단백질들을 Toll-like receptor라고 함. 그렇지만 모든 Toll-like receptor들이 리간드와 결합되었을때 세포내 신호를 일으키는 것은 아니며, 일부 Toll-like receptor는 미생물들이 대식세포와 질 결합하도록 유도하여 식균작용에 의한 파괴를 일으킴. Toll-like receptor은 양상-인식수용체(pattern-recognition receptor, PRR)라 하는 단백질 계열에 속하며, 이들 모두가 다양한 미생물 리간드들에 결합함. 이 리간드들은 일반적으로 그 대응 미생물들 생존에 필수적인 보존성의 분자 양상들을 가짐. PRRs에 의해 인식되는 그와 같은 분자 양상들은 1000여가지로 추정됨.
포유류에서 Toll-like receptor의 중요성은 Toll 4계열중 하나의 변이형을 가지는 생쥐에서 언급된바 있음. 이 생쥐들은 지질 다당류에 대한 과민반응을 보이며 세균감염을 이겨내지 못했음. 최근 사람에 대한 연구보고서에서 자연적으로 생긴 특이 Toll-like receptor 변이체들이 특정 질병들에 걸릴 위험성 증가와 연관되어 있다고 함.
Toll-like receptor은 무척추 동물들에서의 발생 관련인자 그리고 일부 성체 무척추 동물들과 거의 대부분 모든 척추동물들에서 면역학적으로 중요성을 보이므로 현재 생물학자들이 이에 대해 활발히 연구하고 있음. 이 수용체들의 어떤 도메인들은 식물에서도 확인됐고, 식물에서도 질병저항에 관여하는 것으로 보임. 따라서 Toll-like receptor은 생명체 진화에서 미생물 감염에 대한 방어를 위한 첫번째 기전의 하나일 수 있음.
3. 후천성(적응) 면역반응
후천성 면역반응은 매우 복잡하기 때문에 이 반응에 관여하는 여러가지 구성요소를 상세히 설명하기 전에 이에 대한 간략한 소개를 먼저 함.
개요
후천성 면역반응에서는 림프구가 필수적인 세포들임. 선천성 면역과는 달리 림프구는 공격할 특정 외래물질을 인식해야만 함. 그 자신이나 그에 감염된 세포에서 적응 면역반응을 유발시킬 수 있는 외래물질을 항원(antigen)이라고 함. 대부분의 항원은 단백질이거나 분자량이 큰 다당류임. 항원이라는 용어는 기능적으로서 그 위치나 기능에 관계없이 그 자신에 대해 특이 면역반응을 유발시킬 수 있는 분자로 정의함. 따라서 항원은 숙주가 자기 자신으로 인식하지 않는 어떤 분자를 지칭함. 항원은 바이러스의 외투 단백질, 외래 세포상의 특정 단백질들, 일부 암세포들, 이식세포들, 독성물질들을 포함함. 림프구는 서로 다른 항원을 구별할 수 있으며 이는 림프구들이 참여하는 면역반응에 특이성을 제공함.
전형적인 면역반응은 세가지로 나눔. 1) 림프구에 의한 항원의 접촉과 인식2) 림프구의 활성화 3) 활성화된 림프구와 그들의 분비물에 의한 공격의 개시. 3단계로 나눔.
1단계
분화되는 동안 각 림프구는 특정 항원과 결합할 수 있는 한 종류의 수용체를 생성하여, 그 세포막에 삽입시킴. 만약 그 이후 림프구가 동일 항원을 만나면 그 항원은 이 수용체와 결합하게 됨. 이러한 결합을 면역학에서는 물리, 화학적 관점에서 인식(recognition)이라고 함. 따라서 림프구가 항원을 서로 구별하는 능력은 림프구 세포막에 있는 수용체들의 특성에 의해 결정됨. 하나의 림프구는 오직 한 종류의 항원에 특이성을 가짐.
2단계
수용체에 하나의 항원결합이 림프구 활성화(lymphocyte activation)를 일으킴. 항원이 결합되면 림프구는 활성화되어 세포분열을 여러번 반복함. 그 결과로 하나의 전구세포로부터 많은 수의 딸 림프구를 만들어지는 것이며, 이들 각각의 특정 항원인식능은 전구세포와 동일하며, 이를 클론확장(clonal expansion)이라고 함. 일반적으로 보통사람은 약 1억개 이상의 서로 다른 항원수용체를 발현하는 림프구를 가짐. 활성화 된후, 일부 림프구들은 효과기 림프구의 기능을 하여 공격반응을 수행함. 다른 림프구들은 기억세포(memory cell)로 남아 미래 항원의 재침입에 대한 준비를 갖춤.
3단계
활성화된 효과기 림프구들은 면역반응을 유발시킨 모든 종류의 항원에 대한 공격을 개시함. 림프구의 한부류인 활성화된 b세포가 형질세포로 분화되어 생성한 항체를 혈액으로 분비함. 이 항체들이 병원체나 외래물질에 대한 옵소닌으로 작용하여 선천성 면역계세포들에 의해 그들을 공격하게 함. 또 다른 형태의 림프구인 활성화된 세포독성 T세포인데, 이들이 항원을 가지고 있는 세포들을 공격하여 죽임. 일단 공격이 성공적으로 끝나면 B세포, 형질세포 그리고 T세포들의 대부분은 세포자살과정을 통하여 죽게 됨. 이와같이 효과기 세포들이 적절한 시기에 죽는 것은 과다한 면역반응과 자신의 조직파괴를 억제하는 항상성 반응임. 그러나 기억세포들은 면역반응이 성공적으로 끝나도 그대로 유지됨.
림프기관과 림프구의 기원
우선 림프구가 기원하고 존재하는 기관과 조직에 대해 알아본 후 여러종류의 림프구들이 관여하는 개요에 대해 알아봄.
림프기관들
모든 백혈구들처럼 림프구들도 혈액을 통해 순환함. 그러나 어떤 시점에는 대부분의 림프구들이 혈액에서 발견되지 않고, 기관과 조직에서 발견되는데 이 기관들을 림프기관(lymphoid organ)이라고 함. 림프기관은 1차 림프기관과 2차 림프기관으로 나뉨.
1차 림프기관
1차 림프기관은 골수와 흉선임. 이 기관들은 림프구 발생의 개시부위로서 이들이 성숙하기는 했지만 아직 항원자극을 받지 않은 림프구들을 2차 림프기관들에 공급함. 골수와 흉선에 있는 세포들은 면역반응 동안 활성화되지 않음.
2차 림프기관
2차 림프기관은 림프절, 비장, 편도선 등과 소화관, 호흡기관, 생식기관, 비뇨기관의 내벽 등을 포함함. 공급받은 성숙했지만 항원자극을 받지 않은 림프구들이 활성화되어 적응 면역반응을 수행하는 장소가 2차 림프기관임.
골수와 흉선에서 성숙한 림프구를 2차 림프기관으로 보냄. 그러나 2차 림프기관에 있는 대부분의 림프구들은 1차 림프기관에서 유래된 세포는 아님. 일단 골수 혹은 흉선으로부터 유래된 하나의 성숙한 림프구가 2차 림프기관으로 오면 세포분열을 하게 되어 동일한 림프구를 부가적으로 생성하며, 다시 연속적인 세포분열을 하게 됨. 다시 말하면, 2차 림프기관에 있는 모든 림프구들은 골수혹은 흉선에서 성숙한 조상세포의 자손들이지만, 모두가 1차 림프기관에서 유래된 것은 아니라는 것을 의미함. 모든 자손세포들은 하나의 림프구로부터 세포분열하여 만들어진 동일한 림프구의 클론이라는 것을 기억해야 함.
림프기관과 제 12장에서 언급한 림프계에는 차이가 있음. 림프계는 림프관과 림프절의 네트워크를 의미하며, 림프절은 이들 관들을 따라 존재함. 모든 림프기관 중에서 림프절만이 림프기관에 속함.
심혈관계를 통하는 것을 제외하고 여러 림프기관들 끼리는 해부학적인 연결이 존재하지 않음. 제 12장에서 언급한 골수를 제외한 이들 림프기관에 대해 간단히 살펴봄.
흉선(thymus)은 가슴의 윗부분에 존재하는데 크기는 나이에 따라 변하고, 출생시에는 비교적 크고 사춘기까지는 계속 성장하다가 이후로 점차 퇴화하여 지방조직으로 대체됨. 퇴화되기 전에 흉선은 주로 미성숙 림프구들을 포함하고 있지만, 이들은 바로 성숙된 T세포들로 분화되어 혈액을 따라 2차 림프기관으로 이동함. 흉선은 또한 일단의 호르몬을 생성하는 내분비 세포를 가지고 있는데,이 호르몬을 티모포이에틴(thymopoietin)이라 하며, 그 기능은 흉선에서 유래된 림프구의 조절에 관여하는 것으로 알려져 있으나 확실한 기전은 밝혀져 있지 않음.
제 12장에서 언급했듯이 림프액은 림프관을 따라 흐르는 간질액으로서 림프모세관으로 들어가 큰 림프관을 통해 체정맥으로 흘러들어가 혈액과 합쳐짐. 이러한 경로를 지나는 동안 림프액은 림프관에 산재하는 림프절을 통과하게 됨. 그러므로 림프액은 림프절에 있는 림프구가 항원과 만사서 림프구를 활성화시키는 경로가 됨. 각각의 림프절은 림프액으로 채워진 동(sinus)이라는 벌집 모양의 형태로서(그림) 커다란 림프구 집단(림프소절)이 동 사이에 존재함. 림프절에는 또 많은 대식세포와 수지상 세포들이 존재함.
비장(spleen)은 2차 림프기관 중 가장 크며, 위와 횡격막 사이의 복강의 왼쪽에 위치함. 비장과 순환 혈액의 관계는 림프절과 림프액과의 관계와 같음. 많은 수의 림프구, 대식세포 그리고 수지상세포들이 발견되는 비장 안쪽의 혈관망을 통하여 혈액이 스며듬. 비장에 있는 대식세포들은 림프구들과 상호작용하는 것 외에 수명이 다되었거나 죽은 적혈구들을 식작용함.
편도선(tonsil)과 아데노이드(adenoid)는 인두에 있는 작고 둥근 모양의 림프기관임. 이들도 림프구, 대식세포, 수지상 세포들로 채워져 있으며 인두의 표면쪽으로 소낭이 열려있음. 림프구는 흡입된 공기나 음식물 섭취를 통해 들어온 미생물과 반응함. 이와 유사하게 외부로 노출된 여러관들의 표면에 존재하는 림프구들은 관의 안쪽으로부터 침투한 감염물질들과 반응함. 어떤 적당한 시점에서 일부 림프구들은 골수나 흉선을 떠나 2차 림프기관으로 이동함. 대다수의 림프구들은 2차 림프기관, 혈액, 림프액, 그리고 체내의 모든 조직을 서로 왕래함. 2차 림프기관에서 유래된 림프구들은 끊임없이 림프관을 들어가고 나와 혈액으로 운반됨. 동시에 일부 혈액에 존재하는 림프구들은 신체 전체에 퍼져 있는 소정맥의 내피를 통해 간질액으로 들어감. 거기에서 이들은 림프로세관 안으로 이동하여 림프관을 통해 림프절로 이동됨. 상주할 림프절을 선택하기 위해 림프관을 떠나기도 함.
비록 주화성 과정에서 염증부위로 이동하는 림프구들이 증가는 하지만, 이러한 재순환은 감염에 상관없이 계속진행됨. 림프구의 왕복순환은 림프구가 인식할 수 있는 특정 항원과 만날 수 있는 가능성을 크게 증가시킴. 림프구와는 대조적으로 다형핵 과립구와 단핵구는 재순환하지 않음. 이들 세포들은 일단 혈액을 통해 조직으로 들어가면 거기서 죽을때까지 남아있게 됨.
림프구의 기원
림프구의 종류를 18-1에 요약. B림프구는 간략히 B세포라고 하며, B세포들도 골수에서 성숙되어 혈액으로 운반된 후 2차 림프기관들로 이동함.
이러한 성숙과 이동은 일생동안 계속됨. 2차 림프기관에서 세포분열에 의해 만들어진 일련의 모든 세대의 림프구들은 그들의 모세포와 동일함. 즉 이들은 B세포의 클론들임. B세포와는 달리 어떤 림프구들은 태아나 신생아 시기에 미성숙된 상태로 골수를 떠나서 흉선으로 이동되어 2차 림프기관으로 이동되기 전에 성숙함. 이러한 세포들을 T림프구 또는 T세포라고 함. B세포와 마찬가지로 T세포도 2차 림프기관에서 세포분열하여 이의 자손들은 최초의 T세포와 동일한 T세포 클론들임. T세포와 B세포 이외에도 자연살생세포(NK cell)라는 또 다른 종류의 림프구가 있음. 이 세포들도 골수에서 기원하지만 이들의 전구체나 생활사에 대해서는 아직 불분명함. 후에 알겠지만 NK세포는 B세포나 T세포와는 달리 항원에 대해 특이성을 가지고 있지 않음.
B세포와 T세포의 기능들
B세포는 활성화되면 혈질세포로 분화되어 항체들을 혈액으로 분비하는데, 분비된 항체는 온몸으로 순환하면서 그 항체를 형성하게한 항원들과 만나게 됨. 세포밖인 체액에서 항체들이 그 대응 항원들과 결합하여 이들 항원이나 항원을 가지는 세포들을 제거하기 위한 공격을 유도함. 항체-매개 반응(antibody-mediated response)은 체액성 면역이라고도 불리는데, 체액성이라는 용어는 수용성 화학전달자를 통한 상호작용이라는 뜻을 의미함. 항체 -매개 반응은 매우 넓은 범위의 표적들을 담당하며 세포외액에 있는 박테리아나 바이러스 및 미생물들 그리고 독성분자에 대한 주된 방어를 수행함.
체액성 면역과는 대조적으로 T세포 반응은 세포-매개반응임. T세포는 주요 기능성에 의해 세포독성 T세포와 보조 T세포(cytotoxicT cell and helper T cell)의 두종류로 나뉨. 최근에는 억제 T세포 또는 조절 T세포라고 하는 세번째 T세포의 역할이 확실시되어 가고 있음. 이 세포는 B세포와 세포독성 T세포의 기능을 억제한다고 알려짐. T세포를 기능적으로 분류하지 않고 그들의 세포막에 CD4, CD8이라는 특정 단백질의 존재여부에 따라 분류하기도 함. 세포독성 T세포는 CD8을 가지고 있으므로 통상 CD8세포, 보조 T세포는 CD4를 가지고 있으므로 통상 CD4+세포라고 함.
세포독성 T세포는 세포들을 공격함. 활성화 된후 이들 세포들은 표적세포로 이동하여 항원과 결합한 후 화학물질을 분비하여 표적세포들을 직접 죽임. 세포독성 T세포들에 의해 매개되는 이러한 반응은 그의 대상이 암세포 혹은 바이러스, 박테리아, 기생충에 의해 감염된 인체 자신의 세포들이 공격대상이 됨.
주목할 것은 항체-매개반응과 세포독성 T 세포에 의해 매개되는 면역반응에서 위치적 차이가 있다는 것임. 즉 B세포(B세포에서 분화된 형질세포)는 인식작용과 활성화과정이 일어나는 장소가 같음. 형질세포는 항체를 혈액으로 내보내어 면역반응을 유발시켰던 동일한 항원들을 찾게 함.
세포독성 T세포는 직접 혈액으로 들어가 그들의 표적세포들을 찾음.
이제 B세포와 T세포의 일반적 역할에 대해 알아보자.
명칭에서 보듯이 이들의 기능은 공격을 수행하는 것이 아니라 B세포와 대식세포 그리고 세포독성 T세포의 활성화 기능을 수행하도록 도와주는 것임. 보조 T세포는 면역반응의 처음 두단계에 관여함. 첫째, 보조 T세포는 항원과 결합하여 활성화됨. 둘째, 일단 활성화되면 그들은 B세포 활성화가 일어나는 부위로 이동함. 동일한 항원과 결합한 B세포는 그 항원을 활성화된 보조 T세포들에 제시함. 항원-특이 보조T세포는 B세포와 직접 결합하고, 표면 수용체들 간의 소통(시토카인들을 분비와 함께)에 의해 B세포를 활성화 시킴. 세포독성 T세포를 활성화시키기 위해 활성화된 보조 T세포는 다른 세포들(주로 수지상세포로 추정)을 도움.
요약하면, 보조 T세포와 직접 반응하는 B세포와는 달리 보조 T세포가 세포독성 T세포를 활성화하기 위해서는 다른 세포들을 통해 직접적으로 도움. 단지 몇몇 예외를 제외하고는 B세포나 세포독성 T세포가 보조 T세포의 시토카인들 자극을 받지 않으면 이들 두 종류세포들은 적절한 기능을 수행하지 못함. 보조 T세포들을 동일한 종류의 세포집단으로 다루겠지만, 사실 이들은 활성화될때 분비하는 시토카인의 종류에 따라 여러가지 형태로 나뉨. 이러한 다른 종류의 시토카인들이 다른 종류의 림프구, 대식세포 그리고 NK세포들을 활성화시키는 것임. 보조 T세포가 분비하는 일부 시토카인은 염증매개자로서 작용함. 아래 그림은 B세포, 세포독성 T세포 그리고 보조 T세포와의 기본적 상호작용을 요약한 것임.
조절 T세포는 특정 B세포와 세포독성 T세포들이 자기자신의 단백질을 공격하는 능력을 억제하는 것으로 믿고 있음. 따라서 일부 연구자들은 조절 T세포들이 언젠가는 특정 자가면역질환의 치료나 예방에 효과가 있음이 증명될 가능성을 믿고 연구에 박차를 가하고 있음. 또한 조절 T세포들에 의한 억제능에 기초하여 암환자의 세포독성 T세포 활성도를 높이는 방법에 의한 암치료 가능성에 대해 제안하기도 함.
림프구 수용체들
앞서 기술한대로 림프구가 항원들을 구별하는 능력은 림프구의 수용체에 의해 결정됨. B세포와 T세포는 모두 그 세포막에 수용체를 가짐.
B세포 수용체들
B세포는 항원과 보조 T세포의 시토카인에 의해 활성화된 후 분열증식하여 항체를 분비하는 형질세포로 분화되어 항체들을 분비한다는 앞의 내용을 상기해보라. 하나의 특정 B세포에서 분화된 형질세포들은 한 종류의 항체만을 분비할 수 있음. 개개의 B세포는 항상 세포막에 수용체를 가지고 있는데, 이는 이들의 자손인 형질세포의 항체와 복사본의 관계임. 이 표면단백질은 특정항원에 대한 수용체로 작용함.
B세포 수용체와 형질세포 항체로 구성된 단백질을 면역글로불린이라고 함. 비록 B세포의 수용체가 활성화된 B세포로부터 유래된 형질세포의 항체와 동일하지만 기술적으로는 항체라고 하지 않음. 오직 분비된 면역글루불린만 항체라고 함. 하나의 면역글로불린분자는 4개의 서로 연결된 폴리펩티드 사슬들로 구성되어 있음. 아래 그림.
2개의 긴 사슬을 무거운 사슬이라하고, 2개의 짧은 사슬을 가벼운 사슬이라고 함. 면역글로불린은 무거운 사슬과 가벼운 사슬의 일부 아미노산의 서열에 따라 IgA, IgD, IgE, IgG 그리고 IgM의 크게 다섯 종류로 나뉨. 그림에서 보듯이 Fc라 불리는 줄기는 무거운 사슬의 아래쪽 반을 차지하며 무거운 사슬의 윗부분과 이와 결합한 가벼운 사슬은 항원과 결합하는 항원결합부위(antigen binding site)임. 한 종류로 이루어진 면역글로불린 Fc부위의 아미노산 서열은 모두 동일하여 불변부(constant region)라하며, 반면 항원의 결합부위의 아미노산은 면역글로불린마다 서로 다르기 때문에 가변부(variable region)라고 함.
따라서 다섯종류 각각의 항체들은 수백만 종류의 면역글로불린을 형성하며 각각은 하나의 특정항원에 결합함. (매우 유사한 구조를 갖는 항원들의 경우는 하나의 면역글로불린과 결합할 수도 있음). 면역글로불린에 있는 항원결합부위와 항원과의 결합은 단백질에 의한 리간드와의 상호작용인 열쇠와 자물쇠의 관계와 유사함.
또 한가지 중요한 점은 B세포 수용체는 세포외액에 녹아있는 항원뿐 아니라 체액에 존재하는 미생물과 같은 외래세포의 표면에 존재하는 항원과도 결합함. 후자의 경우 B세포는 표면항원과 B세포 수용체간에 결합이 생겨 외래세포와 연결됨. 다시말하면 B세포는 거대분자 또는 생명체 안에 매몰되어 있지 않은 외부항원들을 인식한다는 것임. 요약하면 어떤 동일한 B세포는 특정 항원결합부위를 갖는 수용체를 가지고 있다는 것임. 따라서 인체는 수백만 종류의 서로다른 B 세포들의 클론을 가지고 있으며, 이는 일생동안에 만날 수 있는 방대한 종류의 서로 다른 항원과 대적할 수 있게 됨. 특정 B세포의 세포막에 가지고 있는 수용체로서의 특이 면역글로불린의 형성은 골수에서의 세포들의 성장동안에 결정됨.
여기서 매우 흥미있는 의문을 가지게 됨. 즉 인간의 유전체에서 면역글로불린을 암호화하는 유전자는 불과 200개정도 밖에 되지 않는데, 그러면 인체가 어떻게 해서 이들 유전자로부터 수백만이나 되는 항원결합부위를 가진 서로 다른 면역글로불린을 생성할 수 있는가? 이러한 다양성은 발생과정 중 림프구에서 일어나는 독특한 유전적 공정의 결과인데, 그 이유는 이들 림프구들만이 이러한 공정에 관여하는 효소들을 가지고 있기 때문임. 면역글로불린의 항원결합부위를 암호화하는 유전자의 DNA가 단편조각으로 잘려져서 무작위로 재배열 한 후 재조합되어 새로운 DNA분자들을 형성하게 됨. 이러한 잘려짐과 재조합의 양상이 B세포마다 서로 다르게 일어나서, 면역글로불린 유전자의 방대한 다양성 결과를 갖게 되는 것임.
T세포 수용체
항원에 결합하는 T세포 수용체(T-cell receptor, TcR)도 2개의 사슬로 이루어진 단백질이며, B세포의 경우와 같이 T세포의 클론들마다 서로 다른 특이적 결합부위를 가지고 있음. 그러나 T세포 수용체는 그의 세포막에 결합된 형태로 존재하며 Ig와는 달리 분비되지 않음. B세포의 발생과정의 경우처럼 T세포도 성숙기간 동안 다양한 DNA의 재배열이 일어나며 따라서 수백만의 서로 다른 각각의 T세포 클론들도 고유의 특이성을 가지게 됨. T세포의 이러한 성숙과정은 흉선에서 일어남.
T세포 수용체는 B세포 수용체와 이러한 구조적 차이 이외에 아주 중요한 차이점이 있음. 그것은 T세포의 수용체가 항원과 결합하려면 그 항원이 인체 자신 고유의 어떤 세포막 단백질과의 결합이 선행되어야 한다는 것임. 이것이 선행된 후에야 T세포 수용체가 항원과 자신의 단백질과 결합되어 완전한 복합체가 형성됨. T세포가 인식작용을 수행하기 위해 항원과 결합하여야만 하는 자기자신의 세포막 단백질들은 주조직적합성복합체(major histocompatibility complex, MHC)라는 단일 염색체(6번 염색체) 상의 유전자들에 의해 암호화되는 단백질 군들임. 따라서 이들 단백질을 주조직적합성복합체 단백질(사람의 경우 인간 백혈구 연관항원이라고함)이라고 함. 일란성 쌍둥이를 제외하고는 세포막에 있는 이들 단백질은 사람마다 모두 다름. 근본적으로 MHC단백질들은 세포의 신원확인 꼬리표( “identity tags”) 즉 생물학적으로 자기자신임을 증명하는 유전적 표지들이라고 할 수 있음.
MHC 단백질들은 종종 "제한적 표지들( “restriction elements”)"이라고 하는데, 그 이유는 T세포의 수용체의 항원인식능이 하나의 항원과 하나의 MHC분자와의 복합체 형성이 선행되는 경우에만 일어나는 제한을 받기 때문임. MHC단백질에는 1형과 2형이 있음. 1형 MHC단백질들은 적혈구를 제외한 인체의 모든 세포의 표면에서 발견되며, 2형 MHC 단백질들은 주로 대식세포, B세포, 그리고 수지상세포 등의 표면에서 발견됨. 어떤 조건에서는 그 밖의 세포들에서 2형 MHC가 발현되도록 유도됨.
또 하나의 중요한 점은 T세포 아군들이 모두 동일한 MHC를 필요로 하지 않는다는 점임. 아래표.
세포독성 T세포는 1형 MHC 단백질과 결합된 항원이 요구되며, 반면 보조 T세포는 2형 MHC단백질이 요구됨. 이러한 요구차이에 대한 한가지 이유는 앞에서 언급하였듯이 보조 T세포가 CD4단백질을, 세포독성 T세포가 CD8 단백질을 가지고 있는 것과 연관이 있음. 즉 CD4 단백질은 2형 MHC 단백질과 CD8은 1형 MHC단백질과 결합함.
외래물질인 항원이 어떻게 인체 자신의 세포표면에서 MHC 단백질과 복합체를 형성하는가? 그 답은 아래에 설명할 항원제시(antigen presentation, 항원표출)이라는 과정을 통해서임.
T세포들로의 항원제시
T세포들은 항원이 숙주세포 자신의 MHC단백질과 복합체를 이루어 그 세포막에 나타날때만 결합할 수 있음. 따라서 이와같은 복합체를 형성하여 제시하는 세포를 항원제시(표출) 세포(Antigen presenting cell, APC)라고 함.
보조 T세포로서의 항원제시
보조 T세포가 기능을 하기 위해서는 2형 MHC단백질이 요구됨. 대식세포, B세포 그리고 수지상세포들만이 2형 MHC분자를 표출하므로 보조 T세포에 대한 항원제시세포로서의 기능을 할 수 있음. 보조 T세포에 대한 APC로서의 대식세포 또는 수지상세포의 기능을 모식도로 쉽게 표시할 수 있음. 그림.
이는 이들 세포가 선천성 면역반응과 적응(후천성) 면역반응을 연결해 줌을 보여주는 것이기도 함. 미생물이나 비세포성 항원이 비특이적(선천성) 반응에서 대식세포 또는 수지상세포에 섭식당한 후 그 항원은 이들 세포의 단백질 가수분해효소에 의해 작은 펩티드 조각으로 부분 분해됨. 부수어진 단편조각들은 이어서 이들 세포에서 합성된 2형 MHC단백질과 결합됨(엔도솜안에서). 이 복합체는 세포표면으로 운반되어 세포막에 표출됨. 대식세포(또는 수지상세포)의 표면에 위치한 이 복합체에 특이성을 갖는 보조 T세포가 결합함. 주목할 것은 MHC분자와 결합하여 T세포에게 제시되는 것은 항원전체가 이날 일부 펩티드 조각들이라는 것인데,이 조각들 각각을 항원결정기(antigen determinant) 또는 항원결정부(antigen epitope)라 함. 그럼에도 불구하고 우리는 항원결정기 제시라는 말을 쓰지 않고 통상적으로 항원제시라는 용어를 사용함.
B세포가 보조 T세포에 항원을 제시하는 방법은 바로 위에서 설명한 대식세포와 수지상세포의 경우와 근본적으로 같음. 강조되어야할 것은 항원에 의한 자극에 있어서 B세포가 항원을 분비하는 형질세포로 분화되는 것이 먼저이고, 보조 T세포에 항원제시 능력은 두번째의 기능이라는 점임. 보조 T세포와 APC에 있는 2형 MHC분자와 결합된 항원과의 결합은 보조 T세포의 활성에 있어서 필수적으로 항원-특이적임. 그러나 이 결합자체가 T세포의 활성을 유발하지는 않음. 이외에 보조 T세포와 항원제시세포의 표면에 있는 비항원성 단백질들 간의 상호작용이 일어나는데, 이들 공동자극이 T세포의 활성화에 필요함. 아래 그림참조
마지막으로 항원제시 세포의 항원이 T세포에 결합하여 상호자극하게 되면 항원제시세포에서 많은 양의 시토카인인 인터류킨 1과 종양괴사인자를 분비함. 이들 시토카인은 항원제시세포에 결합된 보조 T세포에 측분비 물질로 작용하여 활성에 필요한 또 하나의 자극제가 됨. 따라서 항원제시 세포는 다음 세가지 방법으로 보조 T세포를 활성화 시킴. 1) 항원제시 2) 비항원성 세포막단백질들의 결합을 통한 상호자극의 제공 3) IL-1, TNF-알파 등의 시토카인 분비임. 이렇게 활성화된 보조 T세포는 그 자신에게 효과를 미치게 하는 자가분비, 인접한 B세포, 세포독성 T세포, 자연살생세포 및 기타 여러세포에게 영향을 주는 측분비의 효과를 갖는 여러종류의 시토카인을 분비함.
세포독성 T세포로서의 항원제시
1형 MHC분자는 모든 유핵세포에서 합성되므로 모든 세포들은 세포독성 T세포에 대한 APC로서 작용할 수 있음. 이러한 특징은 세포독성 T세포의 주요기능(암세포 혹은 바이러스에 감염된 세포가 될 수 있는 인체의 모든 세포를 파괴하는)과도 연관이 있음. 중요한 점은 1형 MHC 분자와 복합체를 형성하는 항원들이 인체 세포내에서 발생한다는 것임.
그와같은 항원들이 어떻게 발생하는 것일까?
바이러스의 경우 숙주안으로 들어오면 숙주세포로 하여금 바이러스의 단백질을 생성하는데, 이 단백질은 그 숙주세포에게는 외래물질로 작용함. 암세포는 화학물질, 방사선 등의 여러가지 요인에 의해 유전자가 변형되어 생성된 것임. 암유전자(oncogen)라 불리는 이 변형된 유전자는 체내에서는 정상적으로는 발견되지 않는 단백질을 생성함. 이러한 단백질들이 항원으로 작용함. 바이러스에 감염된 세포나 암세포에서 생산된 항원 단백질들은 세포내 단백질분해효소에 의해 가수분해되어 펩티드 조각들로 잘림. 이 조각들은 소포체로 이동하여 숙주세포의 1형 MHC분자와 복합체를 형성한 후 세포외 배출작용에 의해 원형질막 표면으로 이동되면,이 복합체의 특이성을 가진 세포독성 T세포가 결합하게 됨. 아래 그림
자연살생세포(NK cell)
앞에서 언급했듯이 자연살생세포는 림프구 종류 중 하나임. 이들은 기능적으로 세포독성 T세포와 여러면에서 비슷함. 예를들면, 이들의 주요 표적은 바이러스에 감염된 세포와 암세포들로서, NK세포는 표적세포와 결합한 후 직접 공격하여 죽임. 그러나 세포독성 T세포와는 달리 자연살생 세포는 항원특이성을 갖지 않음. 즉 각 NK세포는 바이러스에 감염된 세포 혹은 암세포를 특이적인항원인식작용없이 죽일 수 있음. NK 세포는 T세포 수용체나 B세포 수용체인 면역글로불린을 가지고 있지 않으며, 항원을 인식하게 하는 NK세포 수용체의 정확한 특성도 아직 밝혀지지 않은 상태임. NK세포의 활성에는 MHC분자가 관여하지 않음.
그러면 NK세포를 왜 특이적(적응) 면역반응에서 다루는가?
뒤에 설명하겠지만, 그 이유는 NK세포의 활성이 적응면역반응 동안 특정항체들이나 또는 보조 T세포에서 분비되는 시토카인들에 의해 크게 증가하기 때문임.
면역관용의 발생 Development of Immune Tolerance
적응면역반응의 기본틀에서 우리는 또 하나의 결정적인 의문에 대해 고려해야 함. 그것은 우리 인체는 왜 자기자신의 성분에 대해 면역반응을 하지 않는 현상인 면역관용(immune tolerance)을 생성할 수 있는가임. 이것은 항원이 면역반응을 일으키는 외래분자라고 정의한 것임을 감안할때 이상한 질문으로 들릴지도 모름. 그러나 근본적인 질문의 요지는 인체가 특히 단백질들과 같은 자신의 분자들을 어떻게 외래의 것이 아닌 자신의 분자들이라는 것을 알수 있는가 하는 것임.
림프구 수용체의 거대한 다양성은 DNA 사슬이 무작위로 여러조각으로 잘려지고 재조합된 결과임을 상기해보라. 그렇다면 근본적으로는 각 개인이 가지고 있는 림프구 클론들은 그 자신의 단백질과도 결합할 수 있어야 함. 이러한 기능을 가진 림프구들이 출현된다면 그들은 이러한 단백질을 발현하는 세포들과 결합하여 면역학적 공격을 감행하므로 큰 재앙이 될 것임. 자신의 구성성분에 대해 반응하는 활성화된 림프구가 존재하지 않는 이유는 최소한 클론결실(clonal depletion)과 클론 불활성화(clonal inactivation)의 두가지 기전으로 설명가능함.
첫째, 태아시기와 출생초기 동안, T세포들은 흉선에서 여러가지 단백질들에 노출됨. 이들 중 자신의 단백질과 결합능을 가진 T세포들은 세포자살이라는 과정에 의해 파괴되는데, 이것은 클론결실이라고 함. 두번째인 클론 불활성화는 흉선이 아닌 신체의 주변기관에서 일어나는데, 여기서 자신의 성분과 결합하는 능력을 가진 T세포들의 면역반응능이 없어지는 것임.
태아와 발생초기에 일어나는 이러한 클론 결실과 클론불활성화는 어떤 기전에 의해서 일어나는가?
앞에서 언급했듯이, 보조 T세포가 완전하게 활성되려면 특이 항원-특이 자극뿐 아니라 비특이적인 공동자극(T세포와 항원제시세포의 비항원성 단백질과의 보조적 상호작용)이 필요함. 만일 이러한 공동자극이 없다면 보조 T세포는 항원에 의해 활성화되지 못할 뿐 아니라 죽거나 혹은 영원히 불활성화된 상태로 남게 됨. 이러한 면역관용은 생의 초기에 결정됨. 공동자극 분비들의 유도는 활성화된 항원제시 세포들이 요구됨. 톨유사 수용테들과 염증성 시토카인들의 분비를 통한 신호전달이 항원제시세포들로 하여금 T세포 활성화에 공동자극을 제공하는 분자들을 발현시키는 두가지 기전임.
적응면역을 이해하는 전체적인 기본골격은 여기서 마침. 이러한 기본골격을 바탕으로 다음 두 절은 전형적인 면역반응의 시작과 끝을 설명하는 림프구들 간의 상호작용에 주안점을 둘 것이며, 또한 공격기전들의 여러경로에 대해 설명하고자 함.
항체-매개 면역반응들 : 박테리아, 바이러스 및 독소들에 대한 방어
전형적인 항체-매개 면역반응은 박테리아 파괴에 있음. 박테리아 침입에 대한 이러한 일련의 파괴과정을 아래표에 제시.
항원의 인식과 B세포 활성화
이 과정의 처음단계는 박테리아가 체내를 통해 간질액으로 들어오는 선천성(비특이적) 면역반응과 같음. 이들 박테리아는 이어서 림프계와 혈류의 각각 또는 함께 들어가 각각 림프절이나 비장으로 운반됨. 이곳에서 하나의 B세포가 그 수용체 면역글로불린으로박테리아의 표면항원을 인식하고 그 박테리아와 결합함.
몇몇의 경우 박테리아의 세포벽이 다당류 피막으로 둘러싸여 있어서 이러한 결합이 B세포의 활성을 자극시키기에 충분함. 그러나 이렇게 많은 항원에도 불구하고 항원과 결합하는 것만으로는 B세포 활성을 유도할 수 없으며, 항원과 결합한 B세포와 가까이 있는 보조 T세포에서 간질액으로 방출되는 시토카인 형태의 신호들이 요구됨. 보조 T세포는 시토카인 분비에 의해 박테리아와 결합하기 위해서는 항원제시세포에 있는 2형 MHC 분자-항원 복합체와 결합하여야 함. 대식세포가 항원제시세포로서 작용한다고 가정하면, 대식세포가 박테리아를 식균작용한 후 그 단백질을 펩티드 조각으로 가수분해 한 다음, 이 조각과 2형 MHC 분자와의 복합체 형성, 그리고 이 복합체를 대식세포의 세포막에 제시하게 됨. 여기서 이 복합체에 특이성을 가진 보조 T세포가 결합하여 보조 T세포의 활성화가 시작됨.
더욱이 대식세포가 보조 T세포활성화를 도와주는 방법은 이외에도 또 다른 두가지가 존재함. 1) 세포막에 있는 비항원성 단백질을통한 공동자극과 2)인터류킨 1과 TNF-알파 분비임. 공동자극은 보조 T세포를 자극하여 또 다른 시토카인인 인터루킨-2를 분비하게 함. 또 인터루킨 1과 TNF- DKF알파는 보조 T세포로 하여금 인터루키 2에 대한 더 많은 수용체를 발현하게 함. 인터루킨2는 이어서 자가분비 방식으로 활성화된 보조 T세포의 분열을 촉진함. 아래 그림.
세포분열을 통해 형성된 활성화된 보조 T세포 클론들은 인터루킨 2이외에 다른 종류의 시토카인을 분비함. 일단 활성화되면 보조 T세포들은 림프절의 B세포 쪽으로 이동하여 항원제시 B세포들과 반응함. 보조 T세포는 직접접촉과 시토카인 방출에 의한 B세포 활성화를 이끔. 그 외 시토카인들(특히 호염기구에 의해 생성되는 인터루킨 4)도 이 과정에서 역시 중요함. 일단 활성화되면 B세포는 분화하여 특정항원에 대한 항체들을 생산 분비함. 따라서 위 그림에서 보듯이 일련의 단백질 전달자들이 여러 형태의 세포와 서로 연관되어 있으며, 이들 중 보조 T세포가 중심적 역할을 담당함.
그러나 앞에서 언급했듯이 분열되는 B세포의 일부는 형질세포로 전환되지 않고 기억세포로 되어, 앞으로 재침입할 항원에 대해 빠르고 격렬한 면역반응을 수행할 수 있는 특성을 갖게 함. 앞에서는 보조 T세포로 항원을 제시하는 세포로서 대식세포를 예를 들어 설명했지만, B세포도 동일한 역할을 할 수 있음. 보조 T세포의 항원과 결합한 B세포와의 결합이 보조 T세포에서 분비한 시토카인들에 의해 B세포를 최대로 자극하는 것을 확실하게 해줌.
항체의 분비(antibody secretion)
일단 B세포가 형질세포로 전환되면 그들이 죽기전까지 초당 수천분자의 항체를 만듬. 앞서 언급했듯이 항체는 크게 다섯종류로 나뉨. 가장 많이 존재하는 항체가 IgG(감마 글로불린)와 IgM으로서 이들 두종류의 항체가 세포외액에 있는 바이러스나 박테리아에 대한 면역방어를 담당함. IgE는 다세포 기생충에 대한 방어와 알레르기 반응에 관여함. IgA 는 내장관, 호흡기관 및 비뇨생식기관이나 그 표면에 존재하는 형질세포들에서 분비되어, 내표면이나 그 표면에서 국소적으로 면역방어를 담당함. IgA는 또한 젖샘에서도 분비되어 모유의 주된 항체성분이 됨. IgD의 기능은 아직 불명함.
앞에서 우리는 감염시, 감염부위에 가까운 림프절의 B세포와 형질세포들이 항원을 인식하여 항체 생성을 위해 활성화되는 경로들에 대해 알아봄. 주로 IgG와 IgM으로 구성된 항체들은 림프액과 혈액을 통해 순환하다가 감염된 부위로 모이게 됨. 감염된 부위에서 항체는 혈액을 떠나 박테리아의 표면항원과 결합한 후 면역반응을 수행함.
결론적으로 면역반응에서 면역글로불린은 초기 인식과정에서 서로 다른 두가지 역할을 함. 1) B세포 표면에 존재하는 면역글로불린이 항원과 결합하는 것과 2) 형질세포에서 분비된 면역글로불린(항체)이 박테리아의 표면항원과 결합하여 공격할 표적을 표지(marking)하는 일임.
공격 : 항체의 영향(attack : effect of antibodies)
항체는 미생물의 표면에 존재하는 항원과 결합하여 그 미생물을 직접 죽이는 것이 아니라 식균세포(호중구, 대식세포), 보체, 혹은자연살생세포 등과 같은 실질적인 살해기구와 미생물을 물리적으로 연결시켜주는 역할을 함. 항체에 의한 이러한 연결은 공격기전을 작동시킬 뿐 아니라 살해효과가 미생물들에만 한정적으로 일어나게 하는 것임. 특정항체들과의 연결은 인접한 정상구조물들을 살해기전에 의해 발생되는 화학물질들의 독성효과로부터 보호할 수 있음.
식균작용의 직접적 강화
항체는 옵소닌으로 작용할 수 있음. 이 과정은 보체 C3b의 기능과 유사한데, 이 경우엔 항체가 식세포와 항원을 연결해줌. 아래 그림에서 보듯이 식세포는 항체의 Fc부위와 결합하는 막수용체를 가지고 있음. 이러한 연결이 항원과 식세포의 부착과 박테리아에 대한 식균작용을 촉진시킴.
보체계 활성화(activation of the complement system)
앞에서 언급하였듯이, 비특이적(선천성) 염증반응에서 혈장내 보체계는 대체적 보체경로(alternative complement pathway)를 통해 활성화됨. 반면 적응면역반응에서 IgG 혹은 IgM이 항원과 결합하여 고전적 보체경로를 통해 보체를 활성화시킴. 이 경로의 첫번째 분자인 C1은 항원과 결합한 항체의 Fc부위와 결합함. 그 결과 C1의 효소부분이 활성화되면서 고전적 보체경로(classical complement pathway) 전과정이 시작됨. 이 일련의 반응의 최종산물인 막공격복합체(MAC)는 항체가 결합된 상태에서 박테리아의 세포막을 파괴시켜 내용물을 유출되게 하여 세포를 죽임. 이외에도 그림에서 보았듯이 또 다른 활성화된 보체분자(C3b)는 옵소닌으로 작용하여 호중구와 대식세포에 의한 식균작용을 촉진시킴. 따라서 항체는 직접적으로도 그리고 보체 C3b의 활성화를 통해 식균작용을 촉진시킴.
C1이 항체의 항원결합부위가 아닌 Fc부위에 결합하는 것에 주목할 필요가 있는데, 이는 보체분자가 항원과 결합하고 있는 모든 종류의 IgG와 IgM이 결합할 수 있다는 것을 의미함. 다시 말하면, 보체분자는 단지 하나의 세트로 구성되어 있으며 단일 활성화되면 특정 침입자의 인식과 관계없이 동일한 임무를 수행한다는 것을 말함.
항체-의존성 세포독성(Antibody-dependent cellularr cytotoxicity)
특정 보체분자(C1)와 식세포는 모두 항원과 결합한 항체의 Fc부위와 비특이적으로 결합하며 또한 NK세포도 그러함. 따라서 항체는 표적세포를 NK세포와 연결시킬 수 있으며 연결된 NK세포는 독성화학물질을 분비하여 표적세포를 직접 죽임. 이러한 과정을 항체-의존성 세포독성(ADCC)라고 하는데, 그 이유는 세포독성(죽임)이 세포에 의해 수행되며 이러한 과정이 항체가 존재해야만 이루어지기 때문임. 주목할 것은 항체 의존성 식균작용이나 보체활성과 마찬가지로 ADCC에 특이성을 부여하는 것은 항체임. NK세포를 끌어들이는 이와같은 기전은 예외적인 것인데, 이는 앞에서도 언급했듯이 NK세포들이 표적을 확인하는 기전생성이 불명확하다는 것을 말해줌.
박테리아의 독소들과 바이러스의 중화작용
박테리아가 세포외액으로 분비하는 독소들은 항원으로 작용할 수 있어서 항체의 생성을 유발함. 생성된 항체는 유리독소들과 결합하여 독성물질에 감수성을 갖는 세포들과의 상호작용을 억제함. 하나의 항체는 항원과 결합하는 부위가 2개 존재하므로 덩어리로 된 사슬 모양의 항원-항체 복합체로 형성되어 식균작용을 당함. 이와 비슷한 방식으로 세포외액에서 바이러스를 제거하는 기전이 항체에 의해 매개됨. 바이러스 표면의 일부가 항원으로 작용하여 항체가 이에 결합하여 바이러스가 숙주세포의 세포막에 부착하는것을 막음. 이 과정은 바이러스가 숙주세포로 들어가는 것을 억제함. 박테리아의 독성물질의 경우와 마찬가지로 항체-바이러스 복합체의 사슬이 형성되어 식귬작용이 될 수 있음.
능동적 체액성 면역과 수동적 체액성 면역
외래항원 침입에 대한 항체의 생성기구는 매우 다양한데, 특히 항체를 생성하는 기구는 이전에 그 항원에 노출되었는지의 여부에 따라 상당히 좌우됨. 항체의 생성은 첫번째로 항원에 노출된 후 서서히 증가하다가 동일한 항원을 다시 주사하면 즉각적으로 상당히 많은 양의 특이항체가 생성됨. 아래그림
기억 B세포에 의해 이루어지는 이러한 반응은 특정 미생물에 대한 저항성을 크게 강화시킴. 인체 자신이 이러한 미생물이나 이들이 분비한 독성물질, 혹은 다른 항원요소와 접촉하여 생성시킨 이러한 저항성을 능동면역(Active immunity)라고 함. 20세기의 어떤 시기까지 능동적 면역을 얻는 방법은 감염이라는 고통에 시달려야 했지만, 지금은 미생물 유도체가 들어있는 백신의 주사가 사용됨. 백신은 살아있거나 죽은 적은 양의 미생물이나 미량의 독소 혹은 미생물이나 그 독소에서 유래한 무해한 항원분자 등이 구성성분이 됨. 능동적 면역반응을 빠르게 유도할 수 있는 물질을 체내에 노출시킨 후 특정 유기체의 침입에 빠르고 효과적으로 반응할수 잇는 기억세포를 유도하는 것임.
또 다른 면역은 수동면역(passive immunity)라고 하는데, 이는 어떤 사람의 항체를 다른사람에게 공급하여, 공급을 받은 수혜자가 기능을 가진 항체들을 갖게 하는 것임. 이러한 공급은 어머니와 태아사이에서도 일어나는데, 이는 IgG가 태반을 통과할 수 있기 때문임. 또한 모유를 먹는 아이는 어미니의 젖으로부터 IgA를 받음. 이것은 항체의 생성능력이 상대적으로 약한 영아를 1개월동안 보호해주는데, 아주 중요한 요소가 됨.
같은 원리로 임상적으로 사용되는 경우가 있는데, 특정 항체(유전공학적으로 생산된)나 감마-글로불린을 간염같은 감염성 질환을 앓고 있는 사람에게 투여하는 것임. 항체는 제한된 수명을 가지고 있는 단백질이기 때문에 항체의 투여에 의한 보호의 한계는 상대적으로 짧아서 보통 몇주 혹은 몇달밖에 지속되지 않음.
요약
이제 우리는 박테리아의 감염에 대한 저항에 있어서 선천성 면역과 후천성면역 반응 사이의 상호작용을 요약할 수 있음. 생체가 처음으로 특정 박테리아와 접하게 되면 선천성 방어기전에 의해 그들의 침입을 막을 것이며, 만일 체내로 들어왔다 하더라도 식균작용과 염증과정으로 이들을 제거하는 시도가 있게 됨. 동시에 박테리아의 항원들은 특정 B세포 클론들을 항체 형성능력을 가진 형질세포들로 변환시킴.
만일 선천성 면역반응이 급속도로 성공하게 되면, 특이적 면역반응은 느리게 진행되어 중요한 역할을 담당하지 못하게 됨. 만일 선천성 면역반응이 부분적으로만 성공한다면 감염은 계속 진행되어 상당량의 항체들이 생성됨. 항체의 출현은 박테리아에서 분비도니 독소들을 중화시킬 뿐 아니라 식균작용을 촉진하고 직접 외래세포들을 파괴시킴. 동일형의 박테리아가 재침입하게 되면, 특이적 면역반응은 더 즉각적이며 강한 강도로 활성화 될 것임. 그 사람은 그 특정 박테리아들에 대해 능동적 면역을 갖게 됨. 세포외액에 존재하는 바이러스에 대한 방어도 이와 비슷하게 진행되어 그 바이러스를 파괴하거나 중화시키게 됨.
바이러스에 감염된 세포와 암세포에 대한 방어기전
앞절에서 항체-매개 면역반응이 체내로 들어온 박테리아나 바이러스 혹은 개별적인 항원분자들인 외인성 항원분자들에 대해 어떻게 장기간 방어를 구성하고 세포외액의 면역체계에 의해 접할 수 있는지에 대해 설명하였음. 이 절에서는 바이러스나 다른 미생물에 의해 감염된 인체 자신의 세포들 혹은 암세포로 전환된 세포들을 어떻게 파괴되는가에 대해 다룰 것임.
바이러스에 감염된 숙주세포의 파괴는 어떤 가치가 있는가?
이러한 파괴는 바이러스를 세포외액으로 방출하게 되며 방출된 바이러스는 앞에서 언급했듯이 순환하는 항체에 의해 중화됨. 일반적으로 아주 적은 수의 숙주세포만이 이러한 방법에 의해 희생됨. 그러나 일단 바이러스가 복제할 수 있는 기회가 주어져서 세포에서 세포로 퍼져 나간다면 바이러스에 감염된 수많은 숙주세포들이 신체 자신의 방어기전에 의해 죽을 것이며, 이는 곧 그 기관의 기능저하를 초래하게 됨.
세포독성 T세포의 기능
아래 그림은 바이러스에 감염된 신체의 세포에 의해 활성화된 전형적인 세포독성 T세포의 반응을 요약한 것. 암세포의 반응도 이와 유사함. 앞서 언급했듯이 바이러스에 감염된 세포나 암세포는 외래 단백질(foreign protein) 즉 내생적 항원(endogenous antigen)들을 생산하는데 이들은 공정처리되어 1형 MHC 단백질과 복합체를 형성하여 원형질막에 제시됨. 특정 항원에 특이성을 가진 세포독성 T세포는 B세포의 경우와 마찬가지로 이 복합체와 결합할 수 있지만 단지 항원과 결합하는 것만으로는 세포독성 T세포를 활성화시키지 못함. 활성화를 위해서 인접해 있는 활성화된 보조 T세포들에서 분비되는 시토카인이 필요함.
이런 경우 보조 T세포들이 어떻게 역할을 할 수 있는가? 위 그림이 이러한 기전을 가장 가깝게 설명하고 있음. 대식세포들이 세포외액에 있는 유리바이러스나 암세포 그리고 암세포의 표면에서 방출된 항원들을 식작용하고, 이 항원들을 공정처리하여 2형 MHC단백질들과 함께 결합시켜 보조 T세포에게 제시함. 이외에도 대식세포는 상호자극을 제공하고 또한 IL-1과 TNF-알파를 분비함. 활성화된 보조 T세포들은 IL-2와 다른 시토카인들을 분비하는데, IL-2는 자가분비물질로 작용하여 보조 T세포 자신의 세포증식을자극함.
IL-2는 또한 바이러스에 감염된 세포나 암세포의 표면과 결합한 세포독성 T세포에게 측분비 물질로서 작용하여 세포의 증식을 촉진함. 활성화된 보조 T세포에서 분비된 다른 시토카인들도 동일한 기능을 수행함. 표적세포에 결합한 세포독성 T세포가 이미 존재하는데, 왜 세포의 증식이 중요한가? 그 이유는 바이러스에 감염된 세포나 암세포가 하나인 경우는 매우 드물기 때문임. 특정항원에 대한 인식능력이 있는 세포독성 T세포의 클론들을 확장시켜 증식되면, 이들 특이성을 갖는 세포독성 T세포들이 바이러스에 감염된 세포나 암세포를 만날 수 있는 가능성이 증가함.
활성화된 세포독성 T세포가 표적세포를 죽이는 기전은 여러가지가 있는데, 그 중에서 가장 중요한 것은 다음과 같음. 세포독성 T세포는 세포외 배출작용에 의해 분비소포를 그 자신과 그와 결합된 표적세포 사이에 분비함. 이들 소포속에는 퍼포린(pore-formingprotein, perforin)이라는 단백질이 들어있으며 이 단백질은 마치 보체계의 막공격복합체와 유사한 구조를 가짐. 퍼포린 작용의 정확한 과정에 대한 것은 현재로서는 잘 모름. 한때는 퍼포린이 표적세포의 막에 삽입되어 막을 관통하는 채널을 형성하여 이곳으로 세포독성 T세포들에서 방출되는 세포독성물질들이 들어오고 또한 표적세포들의 내용물이 흘러나와 죽게 되는 것으로 믿었었음. 그러나 현재는 적어도 한가지 기전이 인정되고 있는데, 그것은 퍼포린이 세포독성 T세포들이 방출하는 그랜자임(granzyme)이라는 세포독성 효소들을 감염세포로의 운반을 촉진한다는 것임. 퍼포린은 특이성을 갖지 않기 때문에 단단히 부착된 세포독성 T세포와 표적세포사이의 공간으로 방출됨으로써 주변의 무고한 숙주세포가 이 단백질로부터 공격을 받지 않음. 일부 세포독성 T세포들은 초기 항원의 자극에 의해 증식할 때 완전한 활성과정을 거치지 않고 기억세포로 남음. 따라서 세포독성 T세포도 B세포처럼 능동면역이 존재함.
자연살생세포와 활성화된 대식세포의 기능
세포독성 T세포가 바이러스에 감염된 세포나 암세포를 공격하는 매우 중요한 세포이지만 이외에도 또 다른 공격세포들이 존재함. NK세포와 활성화된 대식세포 또한 독성화합물질을 분비하여 표적세포를 파괴함. 항체 의존성 세포독성(ADCC)에서 언급했듯이 NK세포는 항체에 의해 표적세포와 결합할 수 있으며 이것이 바이러스에 감염된 세포들이나 암세포들에 대한 역할의 한 부분을 차지함. 그러나 대부분의 경우 강한 항체반응은 바이러스에 감염된 세포나 암세포에 의해 개시되지 않음. NK세포는 항체의 도움없이 직접 표적세포에 결합할 수 있음. 앞서 언급했듯이 NK세포는 항원특이성을 가지고 있지 않으며 바이러스에 감염된 세포나 암세포에 선천성으로 결합함.
자연살생세포를 증식시키고 독성 화합물질을 분비시키게 하는 주된 신호는 표적세포들에 의해 특이적으로 활성화된 보조 T세포들에서 분비된 IL-2와 인터페론의 한종류인 감마-인터페론임. 그림. 모든 신체의 세포들은 다른 1형 인터페론을 생산할 수 있지만 감마-인터페론은 활성화된 보조 T세포와 NK세포만이 생산할 수 있음.
따라서 NK세포의 공격은 선천성(비특이적)이지만 이 세포가 역할을 하기 위해서는 보조 T세포가 가지고 있는 특이적 면역반응이 필요함. 더욱이 이 과정에서는 활성화된 NK세포들 자신이 감마-인터페론을 분비하는 양성 되먹임 작용이 존재함.
IL-2와 감마-인터페론은 NK세포뿐만 아니라 대식세포에서도 작용하여 암세포나 바이러스에 감염된 세포 및 다른 미생물들을 죽이는 능력을 강화시킴. IL-2와 감마-인터페론에 의해 자극된 대식세포를 활성형 대식세포(activated macrophage)라고 함. 식균작용에 더하여 활성형 대식세포들은 여러기전으로 세포들을 죽일 수 있는 다양한 화학물질들을 대량 분비함. 감염 부위에 병원체가 존재하는 한 활성형 대식세포들은 면역반응을 유지할 수 있는 T세포들에게 항원제시를 계속함. 감염균들을 죽인 다음에는 조직수선이 계속되고, 병원균에 의한 T세포 활성화는 더이상 없으므로 면역반응은 약화됨.
아래표는 이장에서 다룬 바이러스 침입에 대한 방어기전을 요약한 것임.
4. 감염에 대한 전신적 징후
감염에 대한 전신의 반응은 다양함. 즉 기관과 조직의 반응은 감염된 부위나 면역반응이 일어난 부위와 멀리 떨어져 있음. 이러한 전신반응을 모두 급성기 반응(acute phase response)라고 함. 아래 그림.
이들은 당연히 질병의 일부로 생각하겠지만, 사실상 대부분은 감염에 대한 신체자신의 면역반응을 나타내는 것임. 가장 일반적인 감염에 대한 전신의 신호는 열(fever)이며 이에 대한 기전은 제 16장에서 설명함. 제시된 증거는 열이 종종 우리 몸에 유익하게 작용하는데, 그 이유는 체온의 증가가 많은 보호반응을 촉진시키기 때문임. 혈장내의 철과 아연의 농도 감소는 감염에 대한 반응으로서도 일어나고, 간, 비장 그리고 다른 조직내에서의 이 미량원소의 흡수 또는 방출에 의해서도 야기됨. 혈장내에서의 철의 감소는 적응치를 가지고 있는데, 그 이유는 박테리아 증식에 높은 농도의 철이 필요하지 않기 때문임. 아연의 감소에 대한 역할은 아직 밝혀져 있지 않음.
감염에 대한 또다른 적응반응은 간에서 분비되는 급성기 단백질(acute phase pretein)임. 이들 단백질은 염증반응에서 많은 효과를나타내며 특히 국소적 조직손상을 최소화시키는데 관여함. 이외에도 이들은 조직수선과 세포조각이나 미생물에서 분비된 독소들의제거에도 중요한 역할을 함. 예를들어 C-반응 단백질이라는 급성기 단백질은 식균작용을 촉진하는 비특이적 옵소닌의 기능을 함.
감염에 반응하는 골수에서는 호중구와 단핵구의 형성과 분비가 증가함. 근육에서는 또한 아미노산을 분비하는데 이는 감염에 대항하는 단백질이나 조직수선에 필요한 단백질의 합성에 필요한 재료로 사용됨. 또한 지방조직에서는 지방산을 방출하여 에너지원을 제공함. 급성기 반응동안 많은 호르몬(특히 코르티솔)의 분비가 증가하여 면역반응에 대한 음성되먹임 작용을 수행함.
이러한 모든 전신반응은 활성화된 대식세포들이나 다른 세포들에서 분비하는 하나 이상의 시토카인들에 의해서 일어남. 특히 IL-1, TNF-알파, 그리고 다른 시토카인인 IL-6 등 모두는 면역반응에서 국소적으로 작용하고 열과 같은 원거리 반응을 일으키는 호르몬으로서도 작용함. 이외에도 다른 여러 시토카인들이 급성기 반응에 관여하는 것으로 알려져 있음. 예를들어 대식세포, 림프구, 내피세포, 섬유아세포에서 분비되는 콜로니 자극인자(CSF)는 골수를 자극하여 더 많은 호중구와 단핵구를 생성하게 함. 급성기 반응에 대한 대식세포의 역할은 아래 표에 요약함.
5. 감염에 대한 저항을 변형시키는 요인들
많은 요인들이 감염에 대항하는 신체의 능력을 결정하는데 이들 중 중요한 몇가지 예를 들어본다. 단백질-칼로리 영양실조는 전 세게적으로 감염에 대한 저항성을 감소시키는 단일 요소로서 가장 큰 요인임. 그 이유는 단백질 합성에 필요한 아미노산들이 적어서 면역반응을 적절하지 못하게 하기 때문임. 단백질 뿐만 아니라 다른 영양소의 결핍도 감염에 대한 저항성을 떨어뜨림.
기존에 존재한 감염성 혹은 비-감염성 질병도 또한 감염에 노출될 수 있음. 예를들어 당뇨병에 걸린 사람은 최소한의 백혈구 기능저하로 인하여 감염에 민감해짐. 더욱이 조직의 상해가 저항성을 감소시키는데, 이는 아마도 화학적 환경의 변형 혹은 혈액공급의 방해에 의한 것임. 스트레스와 정신적인 상태는 모두 감염과 암에 대해 저항성을 강화시키거나 혹은 약화시킬 수 있음. 정신과 신체간의 상호작용에는 여러기전이 존재하며 이것을 다루는 학문을 정신신경면역학(psychoneuroimmunology)라고 함.
예를들어 림프조직에도 신경이 분포되어 있으며 면역반응을 중재하는 세포들은 많은 신경전달자와 호르몬에 대한 수용체를 가지고있음. 역으로 이미 아는 바와같이 면역세포에서 분비된 일부 시토카인들은 뇌와 내분비계에 중요한 영향을 미침. 더욱이 림프구들은 내분비선에서 생성하는 호르몬과 동일한 호르몬을 분비하기도 함. 따라서 면역계는 신경과 내분비의 기능을 변형시키기도 하며, 역으로 신경계와 내분비계의 활성은 면역기능을 변형시키기도 함. 예를들어 생쥐와 쥐에서 항체의 생성이 정신적인 조건에 의해 변할 수 있음을 보여줌. 만약 사람에게서도 그와 같다면, 언젠가는 자가면역질환을 가진 사람의 면역활성을 조절하는 의료적 처방에 부분적으로 반영될 수 있을 것으로 생각됨.
육체적인 운동이 감염 혹은 암에 대한 저항성에 어떤 영향을 미치는가에 대해서는 수십년 동안 논쟁이 있어왔음. 오늘날에는 운동의 강도, 기간, 지속성, 심리적 스트레스 등의 모든 요소가 면역기능을 증가시키거나 감소시킬 수 있는 중요한 영향요인으로 입증되고 있음(예로 순환 NK세포들의 수). 이 분야의 대다수 전문가들은 이러한 모든 복잡성에도 불구하고 적당한 운동과 신체적 조건은 전체적으로 면역계와 저항성에 좋은 효과를 가져다 준다고 믿고 있음.
또 다른 중요요인이 면역기능의 저하가 수면부족과 연관이 있다는 것임. 예를들어 하루 수면시간의 절반 밖에 자지 못한 사람은 혈액내의 자연살생세포의 수가 감소하는 것으로 관찰되었음. 그러나 그 기전은 아직 잘 밝혀지지 않고 있음. 만일 기본적인 저항기전자체에 결핍을 가지고 있는 사람은 감염에 대한 저항성이 감소할 것임. 이러한 사람들은 감염의 빈도가 잦으며 가끔씩 생명을 위협하는 경우도 발생함. 이것은 감마-글로불린의 주입으로 예방할 수 있음. 또 다른 유전적 결핍의 예가 중증 복합면역결핍(severe combined immudeficiency)인데 이 경우는 B세포와 T세포 모두 결여되어 있는 상태임. 이러한 질병을 가지고 있는 영아를 치료하지 않으면 무차별적인 감염으로 인해 1년이내에 사망함. SCID는 골수의 이식으로 치료될 수도 있음.
이 경우 이식된 골수에서 B세포와 흉선으로 이동되어 T세포로 분화될 세포들을 만들게 되는 것이지만, 이러한 이식은 쉽지 않으며항상 성공하는 것도 아님. 최근에 조혈계 세포들을 표적으로 하는 바이러스 벡터를 사용하여 결손 유전자복구를 위한 유전자치료가 몇몇 SCID환자에서 성공사례가 보고었음. 면역글로불린 생성에 필요한 한 효소, 퓨린대사의 독소 부산물에 대항하는 면역 림프구 보호를 담당하는 효소를 포함한 몇가지 여러 유전자들의 결손이 증명됨. 환경요인들이 백혈구의 감소 또한 저항성을 낮추는 중요한 원인이 됨. 예를들어 조직이나 기관(장기)이식 거부반응을 억제하는 약을 투여한 사람에게 나타날 수 있음. 많은 사람들이 관심을 가지고 있는 점을 본다면 가장 중요한 저한 기전의 결핍의 예는 소위 "후천성 면역결핍증"일 것임.
후천성 면역결핍증
후천성 면역결핍증(acquired immune deficiency syndrome)은 면역계를 무력화시키는 인간 면역결핍바이러스에 의해 일어남. HIV는 유전자가 DNA가 아닌 RNA인 리트로 바이러스에 속함. 레트로바이러스는 역전사 효소를 가지고 있어서 일단 숙주세포내로 들어가면 바이러스의 RNA를 DNA로 전사한 후 숙주세포의 염색체와 결합함. 세포내에서 바이러스의 복제는 숙주세포를 죽이는 결과를 초래함.
HIV는 주로 보조 T세포내로 들어감. 보조 T세포의 세포막에 있는 CD4단백질이 HIV의 표면단백질(gp120)의 수용체로서 작용하여 HIV가 이들 세포에 감염됨. 따라서 보조 T세포가 바이러스와 결합하여 세포내로 들어가는 것이 가능하게 됨. 더 중요한 것은 이러한 HIV gp120 단백질이 CD4에 결합하는 것만으로는 HIV가 보조 T세포로 들어가지 못한다는 것임. 이외에도 정상적으로 케모카인 수용체의 역할을 하는 보조 T세포의 표면단백질이 gp120의 공동수용체로 작용해야만 함. 실제로 이런 케모카인 수용체에 돌연변이를 가지고 있는 사람은 HIV 감염에 상당한 저항성이 있으며, 이를 근거로 많은 연구자들이 치료의 방법을 모색하고 있음.
일단 보조 T세포내로 들어오면 복제중인 HIV는 직접 보조 T세포를 죽이며 간접적으로 일상의 공격면역에 의해 죽게됨. 면역공격은 바이러스에 감염된 세포를 죽이는 세포 독성 T세포가 담당함. 이외에도 완전히 밝혀지지는 않았지만 HIV는 세포자살이라는 과정을 통해 감염되지 않은 많은 보조 T세포르 죽게함. 보조 T세포가 적정한 수를 유지하지 않으면 B세포나 세포독성 T세포 모두 정상적인 기능을 할 수 없음. 따라서 AIDS 환자는 정상적인 면역체계에서 제거될 수 있는 감염이나 암세포에 의해 죽게됨.
전형적으로 감염후 5년동안은 급속도로 복제하는 바이러스가 계속해서 림프조직에 존재하는 많은 수의 보조 T세포를 죽이지만 이들은 다시 새로운 세포에 의해 대체됨. 그러므로 보조 T세포의 수는 정상적(혈액 1mm3당 약 1천개의 세포)으로 유지되며 징후도나타나지 않음. 그다음 5년동안에 이러한 균형이 깨짐. 혈액내의 보조 T세포의 수는 절반으로 감소하지만 대부분의 사람들은 이제까지도 징후를 느끼지 않음. 그러나 보조 T세포의 수가 계속 감소함에 따라 AIDS징후(박테리아, 바이러스, 곰팡이, 기생충 감염 등)가 시작됨. 카포시 육종과 같은 일부 비정상적인 암 또한 높은 빈도로 발생함.
항생제
주로 박테리아인 미생물에 대한 신체의 저항을 도와주는 가장 중요한 약은 항생제임. 항생제는 박테리아를 죽이는 분자나 물질을 말함. 항생제는 다른 세균주들에 대한 방어를 위해 한 세균주에서 만듬. 20세가 중반까지는 페니실린과 같은 항생제들의 생산이 질병을 치료하는데 획기적인 혁명을 가져옴.
항생제들은 세균 세포벽의 합성, 단백질 합성 그리고 DNA 복제를 포함하여 넓은 범위에서 억제효과를 나타냄. 다행히 이들 반응은 박테리아에 의한 단백질 합성과정이 인간세포의 단백질 합성과 다르기 때문에 인체 자신의 단백질합성과정을 방해하지 않고 억제할 수 있음. 예를들어 에리스로마이신이라는 항생제는 박테리아의 mRNA를 따라 이동하는 리보솜의 이동을 억제함.
항생제 남용의 경우 항생제의 저항성이 심각한 문제임.
6. 해로운 면역반응들
이식거부
조직이나 기관(장기)의 성공적인 이식의 주된 장애물은 면역계가 이식체를 외래물질로 인식하여 공격하는 것임. 이것을 이식거부(graft rejection)이라고 함. 이식거부에서 대식세포와 B세포가 일부 역할을 하지만 주로 관여하는 세포는 세포독성 T세포와 보조 T세포임. 일란성 쌍둥이를 제외하고는 이식된 세포의 1형 MHC 단백질은 수혜자의 것과 다름. 또한 이식된 조직의 대식세포에 있는 2형 MHC단백질도 마찬가지임. 따라서 이 두종류의 MHC 분자는 수혜자의 T세포에 의해 외래물질로 인식되고 보조 T세포의 도움을 받아 수혜자의 세포독성 T세포가 이들 단백질을 파괴함.
이식거부를 줄이는 수단으로 방사선과 약물이 사용됨. 이들은 세포분열하는 림프구를 죽여서 수혜자의 T세포 개체수를 감소시킴. 사이클로스포린이라는 약은 매우 효과적인 이식거부 감소제인데, 이것은 림프구를 죽이지 않고 대신 보조 T세포에서 분비되는 인터루킨 2와 다른 시토카인의 생산을 막음. 이것은 보조 T세포 자신들과 세포독선 T세포의 증식 모두에 필요한 결정적인 신호를 제거함. 합성 부신피질 슽레외드의 다량 투여도 또한 이식거부 반응을 감소시킴.
사이클로스포린이나 합성 부신피질 스테로이드 약물의 문제점 1) 면역억제가 비특이적으로 일어나기 때문에 이들 약물을 투여한 환자는 감염이나 암의 위험성이 증가함. 2) 이들은 독성 부작용을 일으킴. 3) 거부반응을 억제하기 위해서 계속 투여해야
이식체로서의 태아
임신기간동안 태반의 태아 영양아층(trophoblast) 세포들은 모체의 면역세포들과 직접 접촉하는 상태로 놓이게 됨. 태아 유전자의 반이 아버지의 반쪽에서 오기 때문에 이 유전자에서 유래된 모든 단백질은 모체에게는 외래물질이 됨. 그런데 왜 모체의 면역체계가 이런 단백질을 표출하는 영양아층 세포들을 공격하지 않고 태반을 거부하지 않는가? 어려운 문제임. 하나 확실한 기전은 다음과 같음. 영양아층 세포들은 실제로 다른 모든 유핵세포와는 달리 1형 MHC단백질을 표출하지 않음. 대신에 그들은 모체의 면역세포들이 외래물질로 인식하지 않는 독특한 1형 단백질을 표출함.
수혈반응
수혈반응(transfusion reaction)은 수혈하는 동안 적혈구를 파괴하는 병으로 일종의 조직거부 반응의 특별한 예임. 그 이유는 때때로 이 거부반응이 세포독성 T세포가 아닌 주로 항체들에 의해 이루어지기 때문임. 적혈구는 MHC단백질을 가지고 있지는 않지만 원형질막에 단백질들과 탄수화물들(지질들에 의해 막에 연결)이 존재하여 다른 사람의 혈액에 노출되면 항원으로 작용할 수 있음.탄수화물들로 이루어진 ABO계가 수혈반응에서 가장 중요함.
어떤 사람은 A항원을 합성하는 유전자를 가지고 있고, 어떤 사람은 B항원 유전자, 또 어떤 사람은 AB모두 또 어떤 사람은 둘 모두를 가지고 있지 않음. (유전자는 항원으로서의 기능을 하는 탄수화물을 직접 만들지는 못하고, 탄수화물의 합성을 촉매하는 효소를생산함). 이 두 종류의 유전자 모두를 가지고 있지 않은 적혈구를 O형 적혈구라고 함. 따라서 생성될 수 있는 혈액형은 A, B, AB,O형이 됨. 아래 그림
A형인 사람의 혈장은 항상 항-B항체를 가지고 있으며, B형인 사람은 항-A항체를 가지고 있고, AB형은 항-A 항체와 항-B 항체 모두를 가지지 않음. O형인 사람은 항-A항체 및 항 -B항체를 모두 가지고 있음. 이러한 항 적혈구 항체들을 자연항체라고 함. 어떻게 자연적으로 일어났는지(즉 항원을 표출한 적혈구의 노출없이도 항체가 만들어지는) 아직 명확히 밝혀지지 않음.
이러한 정보를 배경으로 만일 A형인 사람이 B형의 혈액을 수혈받았다면 어떤일이 일어날지는 우리가 예상할 수 있음. 여기에는 2개의 부적합성이 존재함. 1) 수혈자의 항-B항체가 공여자로부터 수혈된 세포를 공격함. 2) 수혈된 혈장에 존재하는 항-A 항체가 수혈받는 사람의 항체에 의해 수혈된 세포가 파괴되는 것은 문제를 일으킴.
다음과 같은 상황은 수혈된 적혈구가 공격을 받게 됨. B형인 사람이 A형이나 AB형으로부터 수혈받을 경우, A형인 사람이 B형이나 AB형으로부터 수혈받을 경우, O형인 사람이 A형, B형 혹은 AB형으로부터 수혈받을 경우. 따라서 O형은 만능 공여자가 되며, 반면 AB형은 만능 수혜자가 됨. 그러나 이것은 잘못된 것임. 왜냐하면 적혈구는 ABO식 항원이외에 다른 많은 적혈구항원과 이에 대응하는 혈장항체가 있기 때문임. 따라서 아주 급한 상황이 아니라면 공여자와 수혜자의 혈액을 교차응고검사라는 과정으로 상호부적합성을 조사하여야 함. 슬라이드 글라스 위에 수혜자의 혈청을 공여 예정자의 적혈구와 결합시켜 혼합물의 파괴(용혈)나 적혈구 덩어리(응집) 형성을 광찰함. 역으로 수혜자의 적혈구와 공여 예정자의 혈청과 결합시켜 부적합 여부를 재조사 함.
의학적으로 중요한 또 하나의 적혈구 막의 항원이 존재하는데 이것이 단백질의 Rh계임. Rh의 종류는 40가지가 넘지만 그중 문제가 되는 것은 Rho이며, 붉은털 원숭이에서 처음으로 연구되어서 일반적으로 Rh인자라고 함. 인간 적혈구는 항원을 가지고 있거나(Rh 양성), 가지고 있지 않음(Rh 음성). 미국인들의 약 85%가 Rh양성임.
Rh계 항체는 ABO식의 자연항체와는 달리 다른 사람의 Rh양성 세포에 노출되지 않으면 아무도 항-Rh항체를 가질수 없는 고전적 면역양상을 따름. 만일 Rh음성인 사람에게 Rh양성인 사람의 혈액을 여러번 주입시키면 항-Rh 항체를 갖게 되는데, 이와 같은 경우는 주로 태아와 모체와의 관계에서 주로 일어남. 임신기간 동안 태아 적혈구의 일부가 태반을 통과하여 모체의 순환계로 들어감.만일 모체가 Rh음성이고 태아가 Rh양성이라면 모체가 항-Rh 항체를 합성하게 됨. 이것은 주로 분만시 태반이 분리되는 동안 일어남. 따라서 첫번째로 Rh양성 아기를 임신하였을때는 모체에 의해 항체가 만들어지기 전에 분만이 일어나기 때문에 태아에 아무런 위험을 주지 않음. 그러나 다시 임신을 하였을때 이들 항체가 모체에 이미 존재하고 이것이 태반을 통과해 Rh양성 태아의 적혈구를 공격하고 퍄괴함. 이런 상황에서 태아는 심한 빈혈을 초래하여 태아가 사산됨. 이것을 적아세포증(erythroblasosis fetalis)라고함. 각각의 Rh양성의 임신은 모체가 점점 더 감작화되어 그 위험성이 증가함.
다행히 이러한 질병은 예방할 수 있음. 어머니가 Rh양성 아기를 분만한 후 72시간 이내에 Rh양성 적혈구에 대한 인간의 항체를 주입하면 모체에 섞인 태아의 적혈구가 제거되어 모체가 행체를 생성시키지 않음. 도입된 항체는 결국 분해됨. 혹시 ABO식 혈액형의 부적합도 신생아에게 적아세포증을 유발하지 않을까? 다행히 그렇지 않음.
알레르기(과민증)
알레르기 즉 과민증은 환경의 항원에 대한 면역반응이 인체 자신에게 염증과 손상을 일으키는 질병을 말함. 알레르기를 일으키는 항원을 알러겐이라고 함. 대부분의 알레르겐 자체는 상대적으로 또는 전혀 무해하며, 손상을 입히는 것은 이들에 의한 면역반응임.본질적으로 알레르기는 자극에 대한 부적절한 반응으로서 잘못된 면역반응임. 알레르기와 관련된 용어를 정리해 보기로 함.
과민증은 염증반응을 포함한 서로 다른 면역학적 효과경로에 따라 네가지 형태로 나뉨. 우리가 통상적으로 사용하는 알레르기라는용어는 IgE 항체에 의해 매개되는 이들 중의 하나임. 그러나 여기서 우리는 넓은 의미로서의 과민증과 동의어인 알레르기라는 용어를 사용할 것임. 특정 알레르기로 발전하려면 유전적으로 알레르기에 걸리기 쉬운 경향이 있는 사람이 일차적으로 알레르겐에 노출되어야 함. 이 첫번째 노출은 감작화를 야기함. 이어 후속으로 알레르겐에 노출되면 해로운 면역반응을 불러일으켜서 우리가 질병으로 인식하게 됨. 알레르기 반응의 다양성은 서로 다른 면역학적 경로를 거치게 함. 알레르기 질병은 이러한 기전을 근거로 분류함. 아래 표. 지연성 과민증, 면역-복합체 과민증, 세포독성 과민증, 급성 과민증
어떤 종류의 알레르기에 있어서는 염증반응이 항체와는 무관함. 이것은 염증부위에 있는 항원에 의해 활성화된 보조 T세포에서 현저히 분비되는 시토카인들에 기인함. 이들 시토카인들은 그 자체가 염증 매개체 역할을 하며 또한 대식세포를 활성화시켜 이들로 하여금 강력한 매개체를 분비하게 함. 이 과정은 며칠이 걸리므로 이러한 형태의 알레르기를 "지연성 과민증 delayed hyperensitivity"이라고 함. 투베르쿨린 피부검사 그 한 예임.
이와는 대조적으로 항체에 의해 매개되는 여러형태의 알레르기 반응들도 존재함. 그중 하나의 형태가 면역-복합체 과민증(immune-complex hypersensitivity)임. 이것은 수많은 항체(IgG, IgM)가 유리항원과 결합하여 많은 수의 항원 항체 복합체가 내피세포의 표면에 침전되어 나오거나 모세혈관 특히 신소체의 모세혈관 벽 안에서 걸리게 될때 일어남. 이러한 면역 복합체들이 보체를 활성화하여 복합체를 둘러싼 조직들을 즉시 손상시키는 염증반응을 유발함.
세번째 형태의 과민반응은 세포독성 과민증(cytotoxic hypersensitivity)긴데, 이것은 항체들이 세포-표면-연관 항원들과 결합될때 나타나며, 조직손상이나 수용체 기능의 변화를 이끔. 그 예가 바로 적아세포증임.
급성과민증
항체에 의해 매개되는 좀더 일반적인 알레르기 반응은 일반적으로 반응이 빠르기 때문에 급성 과민증이라고 함. 이들은 또한 IgE항체가 관여하기 때문에 IgE-매개성 과민증이라고 함. 급성 과민증에서는 최초의 항원노출이 항체의 생성을 유발하며 더욱 중요한 것은 능동적 면역을 매개하는 기억 B세포를 생산하는 것임. 재노출되었을때 항원은 더욱 강력한 항체반응을 이끌어 냄. 여기까지는 지극히 일반적임. 그러나 급선 과민반응을 일으키는 특정 항원은 유전적으로 감수성을 가진 사람에게 IgE 항체의 생성을 자극시킨다는 점에서 차이가 있음. IgE가 생산되기 위해서는 B세포에 의해 제시된 알레르겐에 의해 활성화된 특정 보조 T세포가 관여아여야 함. 이들 할성화된 보조 T세포들은 시토카인을 분비하여 B세포들을 IgE를 생성하는 형질세포들로 전환시킴.
형질세포에서 분비된 IgE들은 몸 전체를 순환하고 Fc 결합부위를 통하여 비만세포와 부착하게 됨. 그림.
같은 형태의 항원이 체내로 들어가면 이들은 비만세포와 연결된 IgE와 결합하게 되며, 이것은 비만세포로 하여금 히스타만, 에이코노사이드, 케모카인 등과 같은 많은 염증매개체들을분비하게 함. 이러한 모든 매개체들은 국소적 염증반응을 일으킴. 비만세포에서 일어나는 이러한 일련의 과정은 또한 순환중인 호염기구에서도 일어남.
결과적으로 IgE에 매개되는 알레르기 증상은 염증매개체와 항원-IgE -비만세포의 조합이 일어나는 신체부위의 여러가지 영향을 반영함. 예를들어 전에 넝마풀 화분에 노출된 적이 있는 사람이 다시 이 화분에 노출되면 호흡시 통로에 있는 비만세포의 IgE와 이들항원에 결합함. 그러면 점액분비 증가, 혈류량 증가, 상피표면의 부풀음, 기도를 둘러싼 평활근의 수축 등을 불러일으키는 매개체가 분비됨. 그러면 그 결과로서 충혈, 콧물, 재채기, 고초열에 의한 호흡곤란 등의 증세가 수반됨. 페니실린과 곤충의 독에 대한 급성 과민증도 종종 발생하는데 이것 또한 IgE생성과 관련이 있음.
보통의 알레르기 증상은 항원의 침입여부에 한정되어 있음. 그러나 만일 비만세포나 혈액의 호염기구가 많은 양의 화학물질을 분비하여 순환계로 보내변 증상은 전신에 발생하고 심한 저혈압과 기관세지의 수축이 일어남. 이러한 일련의 반응을 아나필락시스(anaphylaxis)라고 하며, 순환계와 호흡장애로 인한 죽음을 초래할 수 있음. 일부 민감한 사람은 단 한마리의 벌침에 있는 항원에 의해 이 증상이 나타날 수 있음. 급성과민증의 매우 빠른 구성요소가 종종 만성기 반응으로 징행되어 몇시간 혹음 며칠동안 지속됨. 이 기간동안에는 많은 수의 백혈구 특히 호산구가 염증부위로 이동함. 여기에 관여하는 주화성 물질은 알러겐에 의해 활성화된 비만세포들과 보조 T 세포들에서 분비된 시토카인들임. 감염부위에서 호산구들은 매개체들을 분비하여 염증을 지속시키고 조직을 감작화시킴. 그리하여 이후 과민반응을 일으킬때는 적은 양의 알레르겐으로도 가능해짐. 염증반응을 자극하며, 호산구는 여러 독성물질들을 분비하여 기생충에 대한 주요 살해세포로서 작용함. 무해한 물질에 대해 어떻게 이러한 시스템이 유도되는가에 대해 아직 불분명함.
자가면역질환
알레르기가 외래 항원에 대한 부적절한 반응에 의한 반면, 자가면역질환은 인체 자신의 고유 단백질들이 항원으로 작용하면서 야기되는 부적절한 면역공격임. 자가항체와 자가반응 T세포에 의해 매개되는 면역공격이 이러한 단백질을 포함하는 자기자신의 세포에게 특이적으로 가해짐. 정상적으로는 인체는 자기자신의 세포에 대해 면역관용의 상태에 있음. 그러나 불행히도 이러한 면역관용이 깨져 인체의 항체-매개에 의해 자신의 세포와 조직을 공격하는 경우가 있음.
인간의 질병들 중 자가면역환으로 밝혀지는 경우가 점점 늘어나고 있음. 다발성 경화증은 신경세포의 수초가 공격을 당하며, 중증근무력증은 골격근 세포의 아세틸콜린 수용체가 표적이 되고, 류머티스 관절염은 관절이 손상되며, 1형 당뇨병은 췌장의 인슐린세포가 파괴됨. 인체가 자신의 세포를 자신의 것으로 인식하지 못하는 몇가지 원인을 아래 표에 요약함.
과다 면역반응
보체나 호중구와 대식세포에서 분비되는 여러 염증매개체들과 독성화합물질들은 그들의 표적에 대해 특이성을 갖지 않음을 상기해보라. 결과적으로 미생물에 대한 염증반응 동안에는 이러한 물질들이 대량으로 생성되거나 방출되어 종종 인접한 정상조직을 손상시킬 수 있음. 이러한 물질들은 또한 치명적인 전신반응을 야기할 수 있음.
패혈성 쇼크는 시토카인의 전신 혈관확장에 의한 저혈압
미생물에 대한 과다 염증에 의해 상해를 입은 또 하나의 중요한 예는 에이즈에서 일어나는 치매현상임.
만성과다 염증반응은 또한 미생물의 감염없이도 일어날 수 있음. 따라서 천식, 류마티스 관절염, 염증성대장질환을 포함하는 여러 주요 질병들이 만성염증질환에 해당함.
혈관에서 죽상경화반이 발생하는 것 또한 비-감염성 과다 염증의 한 예임.